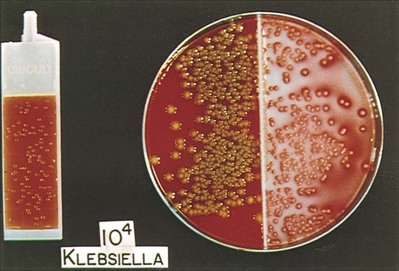

chapter 10 Infections of the Urinary Tract
Urinary tract infections (UTIs) are common, affect men and women of all ages, and vary dramatically in their presentation and sequelae. They are a common cause of morbidity and can lead to significant mortality. Although the urinary tract is normally free of bacterial growth, bacteria that generally ascend from the rectal reservoir may cause UTIs. When bacterial virulence increases or host defense mechanisms decrease, bacterial inoculation, colonization, and infection of the urinary tract occur. Careful diagnosis and treatment result in successful resolution of infections in most instances. A better understanding of the pathogenesis of UTIs and the role of host and bacterial factors has improved the ability to identify patients at risk and prevent or minimize sequelae. Clinical manifestations can vary from asymptomatic bacterial colonization of the bladder to irritative symptoms such as frequency and urgency associated with bacterial infection; upper tract infections associated with fever, chills, and flank pain; and bacteremia associated with severe morbidity, including sepsis and death. New antimicrobial agents that achieve high urinary and tissue levels, that can be administered orally, and that are not nephrotoxic have significantly reduced the need for hospitalization for severe infection. Shorter-course therapy and prophylactic antimicrobial agents have reduced the morbidity and cost associated with recurrent cystitis in women. Although the vast majority of patients respond promptly and are cured by therapy, early identification and treatment of patients with complicated infections that place them at significant risk remains a clinical challenge to urologists.
Definitions
UTI is an inflammatory response of the urothelium to bacterial invasion that is usually associated with bacteriuria and pyuria.
Bacteriuria is the presence of bacteria in the urine, which is normally free of bacteria. It has been assumed to be a valid indicator of either bacterial colonization or infection of the urinary tract. Although this is usually true, studies in animals (Hultgren et al, 1985; Mulvey et al, 1998) and humans (Elliott et al, 1985) have indicated that bacteria may be in the urothelium in the absence of bacteriuria. Alternatively, bacteriuria may represent bacterial contamination of an abacteriuric specimen during collection.
The possibility of contamination increases as the reliability of the collection technique decreases from suprapubic aspiration to catheterization to voided specimens. The term significant bacteriuria has a clinical connotation and is used to describe the number of bacteria in a suprapubically aspirated, catheterized, or voided specimen that exceeds the number usually caused by bacterial contamination of the skin, the urethra, or the prepuce or introitus, respectively. Hence it represents a UTI.
Bacteriuria can be symptomatic or asymptomatic. When it is detected by population studies (screening surveys), screening bacteriuria is a more precise and descriptive term than asymptomatic bacteriuria, especially because the latter term is clinically useful for describing the presence or absence of symptoms in an individual patient.
Pyuria, the presence of white blood cells (WBCs) in the urine, is generally indicative of infection and an inflammatory response of the urothelium to the bacterium. Bacteriuria without pyuria is generally indicative of bacterial colonization without infection of the urinary tract. Pyuria without bacteriuria warrants evaluation for tuberculosis, stones, or cancer.
Infections are often defined clinically by their presumed site of origin.
Cystitis describes a clinical syndrome of dysuria, frequency, urgency, and occasionally suprapubic pain. These symptoms, although generally indicative of bacterial cystitis, may also be associated with infection of the urethra or vagina or noninfectious conditions such as interstitial cystitis, bladder carcinoma, or calculi. Conversely, patients may be asymptomatic and have infection of the bladder and possibly the upper urinary tract.
Acute pyelonephritis is a clinical syndrome of chills, fever, and flank pain that is accompanied by bacteriuria and pyuria, a combination that is reasonably specific for an acute bacterial infection of the kidney. The term should not be used if flank pain is absent. It may have no morphologic or functional components detectable by routine clinical modalities. There may be serious difficulties in diagnosing spinal cord–injured and elderly patients who may be unable to localize the site of their discomfort.
Chronic pyelonephritis describes a shrunken, scarred kidney, diagnosed by morphologic, radiologic, or functional evidence of renal disease that may be postinfectious but is frequently not associated with UTI. Bacterial infection of the kidney may cause a focal, coarse scar in the renal cortex overlying a calyx, almost always accompanied by some calyceal distortion (Fig. 10–1), which can be detected radiographically or by gross examination of the kidney. Less commonly, renal scarring from infection can result in atrophic pyelonephritis or generalized thinning of the renal cortex, with a small kidney appearing radiographically similar to one with postobstructive atrophy (Fig. 10–2).

Figure 10–1 Excretory urogram demonstrates focal, coarse scarring in the right kidney of an 18-year-old girl with a history of many recurrent fevers between 2 months and 2 years of age. A cystogram when the patient was 2 years old established an atrophic left kidney with marked reflux up to the left kidney and slight reflux up to the right kidney. Excretory urography at the age of 6 years established severe atrophy of the left kidney. She had no infections between the ages of 6 and 15 years. Several reinfections occurred at the age of 15 years, and they ceased with prophylactic therapy. Her blood pressure has remained normal, and her serum creatinine level was 0.9 mg/dL at the age of 18 years. At 21 years of age she stopped antimicrobial prophylaxis for 18 months without infections or introital colonization with Enterobacteriaceae. Note that all calyces are blunted and that one extends to the capsule (arrowhead) because of atrophy of the overlying cortex.

Figure 10–2 A, Excretory urogram of the contralateral left kidney from the same patient as in Figure 10–1. The severe pyelonephritic atrophy, undoubtedly caused by febrile urinary infections during early infancy with reflux into different segments of the kidney, produced irregular cortical scarring. Note how all the calyces extend to the capsule with irregular, intervening areas of cortex. B, Pyelonephritic atrophy, suggestive of postobstructive atrophy, in a 20-year-old woman with spina bifida, neurogenic bladder, and many episodes of fever and bacteriuria in early childhood. Observe the uniform, regular atrophy of the renal cortex that suggests reflux of bacteria simultaneously into virtually all nephrons. This type of pyelonephritic atrophy is uncommon compared with that shown in A and is characteristic of obstruction with superimposed infection.
UTIs may also be described in terms of the anatomic or functional status of the urinary tract and the health of the host.
Uncomplicated describes an infection in a healthy patient with a structurally and functionally normal urinary tract. The majority of these patients are women with isolated or recurrent bacterial cystitis or acute pyelonephritis, and the infecting pathogens are usually susceptible to and eradicated by a short course of inexpensive oral antimicrobial therapy.
A complicated infection is associated with factors that increase the chance of acquiring bacteria and decrease the efficacy of therapy (Table 10–1). The urinary tract is structurally or functionally abnormal, the host is compromised, and/or the bacteria have increased virulence or antimicrobial resistance. The majority of these patients are men.
Table 10–1 Factors That Suggest Complicated UTI
Reprinted from Schaeffer AJ. Urinary tract infections. In: Gillenwater JY et al, editors. Adult and pediatric urology. Philadelphia: Lippincott Williams & Wilkins; 2002. p. 212.
Renal diseases that reduce the concentrating ability of the kidney or neurologic conditions that alter bladder-emptying capabilities are commonly encountered functional abnormalities.
Examples of anatomic abnormalities include obstruction associated with calculi or enlargement of the prostate or congenital or acquired sites of residual urine, such as calyceal or bladder diverticula. A complicated infection is frequently caused by bacteria that have exposure to many antimicrobial agents.
Chronic is a poor term that should be avoided in the context of UTIs, except for chronic pyelonephritis or bacterial prostatitis, because the duration of the infection is not defined.
UTIs may also be defined by their relationship to other UTIs:
The term reinfection describes a new event associated with reintroduction of bacteria into the urinary tract from outside.
Bacterial persistence refers to a recurrent UTI caused by the same bacteria reemerging from a focus within the urinary tract, such as an infectious stone or the prostate. Relapse is frequently used interchangeably. These definitions require careful clinical and bacteriologic assessment and are important because they influence the type and extent of the patient’s evaluation and treatment.
Antimicrobial prophylaxis is the prevention of reinfections of the urinary tract by the administration of antimicrobial drugs. If the term is used correctly in reference to the urinary tract it can be assumed that bacteria have been eliminated before prophylaxis is begun. Surgical antimicrobial prophylaxis entails administration of an antimicrobial agent before and for a limited time after a procedure to prevent local or systemic postprocedural infections.
Antimicrobial suppression is the prevention of growth of a focus of bacterial persistence that cannot be eradicated. A low, nightly dosage of an antimicrobial agent usually results in the urine showing no growth, as in the case of a small infectious stone or in bacterial prostatitis caused by Escherichia coli. Suppressive is also a useful term when recurrent acute symptoms are prevented in a poor-risk patient, such as one with a large staghorn calculus in whom the antimicrobial agent reduces but does not eliminate the bacteria in the urine.
Domiciliary or outpatient UTIs occur in patients who are not hospitalized or institutionalized at the time they become infected. The infections are generally caused by common bowel bacteria (e.g., Enterobacteriaceae or Enterococcus faecalis), which are susceptible to most antimicrobial agents.
Nosocomial or health care–associated UTIs occur in patients who are hospitalized or institutionalized, and these are typically caused by Pseudomonas and other more antimicrobial-resistant strains.
Incidence and Epidemiology
UTIs are considered to be the most common bacterial infection. They account for more than 7 million visits to physicians’ offices and necessitate or complicate over 1 million office visits and 1 million emergency department visits, resulting in 100,000 hospitalizations annually (Patton et al, 1991, Hooton and Stamm, 1997; Foxman et al, 2000). They account for 1.2% of all office visits by women and 0.6% of all office visits by men (Schappert, 1997).
The overall prevalence of bacteriuria in women has been estimated at 3.5%, with prevalence generally increasing with age in a linear trend (Evans et al, 1978). Surveys screening for bacteriuria have shown that about 1% of schoolgirls (aged 5 to 14 years) (Kunin et al, 1962) have bacteriuria and that this figure increases to about 4% by young adulthood and then by an additional 1% to 2% per decade of age (Fig. 10–3). Nearly 30% of women will have had a symptomatic UTI requiring antimicrobial therapy by age 24, and almost half of all women will experience a UTI during their lifetime. The prevalence of bacteriuria in young women is 30 times more than in men. However, with increasing age, the ratio of women to men with bacteriuria progressively decreases. At least 20% of women and 10% of men older than 65 years have bacteriuria (Boscia and Kaye, 1987; Juthani-Mehta, 2007).

Figure 10–3 Prevalence of bacteriuria in females as a function of age.
(From Stamey TA. The prevention of recurrent urinary infections. New York: Science and Medicine; 1973.)
The incidence of bacteriuria also increases with institutionalization or hospitalization and concurrent disease (Sourander, 1966). In a study of women and men older than 68 years, Boscia and Kaye (1987) found that 24% of functionally impaired nursing home residents had bacteriuria compared with 12% of healthy domiciliary subjects (Boscia et al, 1986). UTIs account for approximately 38% of the 2 million nosocomial infections each year (Sedor and Mulholland, 1999; Lo et al, 2008). More than 80% of nosocomial UTIs are secondary to an indwelling urethral catheter (Sedor and Mulholland, 1999). The incidence of UTIs is also increased during pregnancy and in patients with spinal cord injuries, diabetes, multiple sclerosis, and human immunodeficiency virus (HIV) infection/acquired immunodeficiency syndrome (AIDS).
The financial impact of community-acquired UTIs is nearly $1.6 billion in the United States alone (Foxman, 2002); the annual cost of nosocomial UTIs has been estimated to range from between $515 million and $548 million (Jarvis, 1996).
Little is known about the natural history of untreated bacteriuria in women because most women are treated when they are diagnosed, but a few studies in which treatment with antimicrobial agents is compared with placebo have been done. These show that 57% to 80% of bacteriuric women who are untreated or treated with placebo clear their infections spontaneously (Mabeck, 1972; Guttmann, 1973). Mabeck (1972) found that 8 of 53 bacteriuric women placed on placebo needed treatment with an antimicrobial agent because of symptoms, but 32 of the remaining 45 women cleared without treatment within a month, and 43 of the 45 had spontaneously cleared of bacteriuria within 5 months; only 2 women remained persistently bacteriuric.
Once a patient has an infection, he or she is likely to develop subsequent infections. Many adults had UTIs as children, underscoring the importance of genotypic factors in UTIs (Gillenwater et al, 1979). Of 45 women with untreated UTIs whose infection cleared, 20 (46%) had recurrences within a year (Mabeck, 1972).
When women with recurrent bacteriuria were observed after treatment, about one sixth (37 of 219) had a very high recurrence rate (2.6 infections per year) whereas the remaining women had a recurrence rate of only 0.32 per year (Mabeck, 1972). Similar separation was seen in a prospective study in which only 28.6% of 60 women who experienced their first symptomatic UTI had recurrent infections over the first 18 months of observation, as opposed to recurrences in 82.5% of 106 women who had had previous UTIs (Harrison et al, 1974). Other investigators also have found that the probability of recurrent UTIs increases with the number of previous infections and decreases in inverse proportion to the elapsed time between the first and the second infections (Mabeck, 1972). Of these recurrent infections, 71% to 73% are caused by reinfection with different organisms, rather than recurrence with the same organism (Mabeck, 1972; Guttmann, 1973).
Women with frequent reinfections have a rate of 0.13 to 0.25 UTIs per month (1.6 to 3.1 infections per year) when the infections are treated with antimicrobial agents (Mabeck, 1972; Guttmann, 1973; Kraft and Stamey, 1977; Vosti, 2002).
In a prospective long-term study of 235 women with more than 1000 confirmed infections studied over a period ranging from 1 to nearly 20 years, about half of the patients had clusters of infections, which ranged in frequency from 2 to 12 infections per cluster. Infections were followed by remission-free intervals that averaged approximately 1 year. Most reinfections occurred after 2 weeks (Harrison et al, 1974) and within 5 months (Mabeck, 1972), and most occurred early in this interval (Kraft and Stamey, 1977; Vosti, 2002) (Fig. 10–4). Rates of reinfection were independent of bladder dysfunction, radiologic changes of chronic pyelonephritis, and vesicoureteral reflux (Guttmann, 1973). The reinfections did not occur evenly over time. In the Stanford series (Kraft and Stamey, 1977), 23 women with frequent recurrent infections were studied with monthly urine cultures when asymptomatic and with immediate cultures when symptomatic for cystitis, for a mean of 3 years. Thirty-four percent of infections were followed by infection-free intervals of at least 6 months (average, 12.8 months), and 22 of the 23 women had such intervals. However, even these long intervals were followed by further infections (Kraft and Stamey, 1977), thus underscoring the importance of genotypic factors in the pathogenesis of UTIs in women (Schaeffer et al, 1981).

Figure 10–4 Days between recurrent UTIs grouped by 30-day intervals.
(From Kraft JK, Stamey TA. The natural history of symptomatic recurrent bacteriuria in women. Medicine 1977;56:55.)
When the Stanford data (Kraft and Stamey, 1977) on recurrent UTIs in highly susceptible females are analyzed by examining sets of infections separated by remissions of at least 6 months, 69% of the sets contain only one infection. After this first set, the remaining sets show a 33% remission rate in infections, which means a patient who has two or more infections within 6 months has only a 33% probability of remaining free of infection for the next 6 months. Therefore, if antimicrobial prophylaxis is started after the second or any succeeding infection within a set, about two thirds of the women will benefit.
Whether a patient receives no treatment at all or short-term, long-term, or prophylactic antimicrobial treatment the risk of recurrent bacteriuria remains the same; prophylactic antimicrobial therapy reduces reinfections but does not alter the underlying predisposition to recurring infection. Asscher and associates (1973) found that reinfections occurred in 17 patients (34%) treated with a 7-day course of nitrofurantoin and in 13 patients (29%) receiving placebo during a 3- to 5-year follow-up. Mabeck (1972) found that 46% (20 of 43) of untreated patients had recurrent infections by 12 months compared with about 40% of treated patients who had recurrences. Both studies suggest that it makes little difference whether a UTI is cured with an antimicrobial agent or is allowed to clear spontaneously—the susceptibility to recurrent UTI remains the same. Moreover, patients with frequent UTI who take prophylactic antimicrobial agents for extended periods (≥6 months) may decrease their infections during the time of prophylaxis but the rate of infection returns to the pretreatment rate after prophylaxis is stopped (Vosti, 1975; Stamm et al, 1980a). Even long interruptions in the pattern of recurrence, therefore, do not appear to alter the patient’s basic susceptibility to infections.
The sequelae of complicated UTIs are substantial. It is well established in the presence of obstruction, infection stones, diabetes mellitus, and other risk factors that UTIs in adults can lead to progressive renal damage (Freedman, 1975). The long-term effects of uncomplicated recurrent UTIs are not completely known, but, so far, no association between recurrent infections and renal scarring, hypertension, or progressive renal azotemia has been established (Asscher et al, 1973; Freedman, 1975). Indeed, one investigator was unable to find a single case of unequivocal nonobstructive chronic pyelonephritis in 22 patients in whom chronic pyelonephritis was the cause of end-stage renal failure (Schechter et al, 1971). Similar data were reported by Huland and Busch (1982).
In pregnant women the prevalence and rate of recurrent infection are the same but their bacteriuria progresses to acute clinical pyelonephritis more frequently than in nonpregnant women. This variation in the natural history of recurrent infections in females is discussed in a later section on UTIs in pregnancy.
Key Points
Incidence and Epidemiology
Pathogenesis
UTIs are a result of interactions between the uropathogen and the host. Successful infection of the urinary tract is determined in part by the virulence factors of the bacteria, the inoculum size, and the inadequacy of host defense mechanisms. These factors also play a role in determining the ultimate level of colonization and damage to the urinary tract. Whereas increased bacterial virulence appears to be necessary to overcome strong host resistance, bacteria with minimal virulence factors are able to infect patients who are significantly compromised.
Routes of Infection
Ascending Route
Most bacteria enter the urinary tract from the bowel reservoir via ascent through the urethra into the bladder. Adherence of pathogens to the introital and urothelial mucosa plays a significant role in ascending infections. This route is further enhanced in individuals with significant soilage of the perineum with feces, women who use spermicidal agents (Hooton et al, 1996; Foxman, 2002; Handley et al, 2002), and patients with intermittent or indwelling catheters.
Although cystitis is often restricted to the bladder, approximately 50% of infections can extend into the upper urinary tract (Busch and Huland, 1984). The weight of clinical and experimental evidence strongly suggests that most episodes of pyelonephritis are caused by retrograde ascent of bacteria from the bladder through the ureter to the renal pelvis and parenchyma. Although reflux of urine is probably not required for ascending infections, edema associated with cystitis may cause sufficient changes in the ureterovesical junction to permit reflux. Once the bacteria are introduced into the ureter, they may ascend to the kidney unaided. However, this ascent would be greatly increased by any process that interferes with the normal ureteral peristaltic function. Gram-negative bacteria and their endotoxins, as well as pregnancy and ureteral obstruction, have a significant antiperistaltic effect.
Bacteria that reach the renal pelvis can enter the renal parenchyma by means of the collecting ducts at the papillary tips and then ascend upward within the collecting tubules. This process is hastened and exacerbated by increased intrapelvic pressure from ureteral obstruction or vesicoureteral reflux, particularly when it is associated with intrarenal reflux.
Hematogenous Route
Infection of the kidney by the hematogenous route is uncommon in normal individuals. However, the kidney is occasionally secondarily infected in patients with Staphylococcus aureus bacteremia originating from oral sites or with Candida fungemia. Experimental data indicate that infection is enhanced when the kidney is obstructed (Smellie et al, 1975).
Urinary Pathogens
Most UTIs are caused by facultative anaerobes usually originating from the bowel flora. Uropathogens such as Staphylococcus epidermidis and Candida albicans originate from the flora of the vagina or perineal skin.
E. coli is by far the most common cause of UTIs, accounting for 85% of community-acquired and 50% of hospital-acquired infections. Other gram-negative Enterobacteriaceae, including Proteus and Klebsiella, and gram-positive E. faecalis and Staphylococcus saprophyticus are responsible for the remainder of most community-acquired infections. Nosocomial infections are caused by E. coli, Klebsiella, Enterobacter, Citrobacter, Serratia, Pseudomonas aeruginosa, Providencia, E. faecalis, and S. epidermidis (Kennedy et al, 1965). Less common organisms such as Gardnerella vaginalis, Mycoplasma species, and Ureaplasma urealyticum may infect patients with intermittent or indwelling catheters (Josephson et al, 1988; Fairley and Birch, 1989).
The prevalence of infecting organisms is influenced by the patient’s age. For example, S. saprophyticus is now recognized as causing approximately 10% of symptomatic lower UTIs in young, sexually active females (Latham et al, 1983) whereas it rarely causes infection in males and elderly individuals. A seasonal variation with a late summer to fall peak has been reported (Hovelius and Mardh, 1984).
Fastidious Organisms
Anaerobes in the Urinary Tract
Although symptomatic anaerobic infections of the urinary tract are documented, they are uncommon. However, the distal urethra, perineum, and vagina are normally colonized by anaerobes. Whereas 1% to 10% of voided urine specimens are positive for anaerobic organisms (Finegold, 1977), anaerobic organisms found in suprapubic aspirates are much more unusual (Gorbach and Bartlett, 1974). Clinically symptomatic UTIs in which only anaerobic organisms are cultured are rare, but these organisms must be suspected when a patient with bladder irritative symptoms has cocci or gram-negative rods seen on microscopic examination of the centrifuged urine (catheterized, suprapubic aspirated, or voided midstream urine) and routine quantitative aerobic cultures fail to grow organisms (Ribot et al, 1981).
Anaerobic organisms are frequently found in suppurative infections of the genitourinary tract. In one study of suppurative genitourinary infections in males, 88% of scrotal, prostatic, and perinephric abscesses included anaerobes among the infecting organisms (Bartlett and Gorbach, 1981). The organisms found are usually Bacteroides species, including B. fragilis, Fusobacterium species, anaerobic cocci, and Clostridium perfringens (Finegold, 1977). The growth of clostridia may be associated with cystitis emphysematosa (Bromberg et al, 1982).
Mycobacterium tuberculosis and Other Nontuberculous Mycobacteria
Mycobacterium tuberculosis and other nontuberculous mycobacteria may be found when cultures for acid-fast bacteria are requested; they do not grow under routine aerobic conditions and may be found during evaluation for sterile pyuria. It has been emphasized that the mere presence of mycobacteria may not indicate tissue invasion. Therefore factors such as symptoms, endoscopic or radiologic evidence of infection, abnormal urine sediment, the absence of other pathogens, repeated demonstration of the organism, and the presence of granulomas should be considered before therapy is instituted (Brooker and Aufderheide, 1980; Thomas et al, 1980). (M. tuberculosis is discussed in Chapter 16.)
Chlamydia
Chlamydiae are not routinely grown in aerobic culture but have been implicated in genitourinary infections. (Their role in the urinary tract is discussed in Chapter 13.)
Bacterial Virulence Factors
Virulence characteristics play a role in determining both if an organism will invade the urinary tract and the subsequent level of infection within the urinary tract. It is generally believed that uropathogenic strains resident in the bowel flora, such as uropathogenic E. coli (UPEC), can infect the urinary tract not only by chance but also by the expression of virulence factors that enable them to adhere to and colonize the perineum and urethra and migrate to the urinary tract where they establish an inflammatory response in the urothelium (Schaeffer et al, 1981; Yamamoto et al, 1997; Schlager et al, 2002; Moreno et al, 2008). The same virulence factors can be found on bacterial strains that cause recurrent UTI in patients (Foxman et al, 1995). Some of these virulence determinants are located on one of approximately 20 UPEC-specific pathogenicity-associated islands ranging from 30 to 170 kb (Hacker, 1999; Oelschlaeger et al, 2002). These pathogenicity islands collectively increase the size of the pathogen genome by about 20% over a commensal strain. A recent genomic analysis of a UPEC strain revealed the presence of genes for putative chaperone-usher systems as well as autotransporter proteins that may function as adhesins, toxins, proteases, invasins, serum resistance factors, or motility mediators (Henderson and Nataro, 2001). One UPEC-specific autotransporter, Sat, seems toxic to urinary tract cells in vitro (Guyer et al, 2000) and can cause cytoplasmic vacuolation and severe histologic damage in mouse kidneys (Guyer et al, 2002). Another toxin, hemolysin HlyA, forms pores in a variety of host cell membranes (Uhlen et al, 2000). In addition to proteases and toxins, UPEC produces several iron acquisition systems, including aerobactin (Johnson et al, 1988; Johnson, 2003) and the more recently described IroN system (Russo et al, 1999; Sorsa et al, 2003). Lastly, most UPEC strains produce an acid polysaccharide capsule that protects the bacteria from phagocytosis by human polymorphonuclear leukocytes and inhibits activation of complement (Johnson, 2003).
Early Events in UPEC Pathogenesis
Bacterial Adherence
Bacterial adherence to vaginal and urothelial epithelial cells is an essential step in the initiation of UTIs. This interaction is influenced by the adhesive characteristics of the bacteria, the receptive characteristics of the epithelial surface, and the fluid bathing both surfaces. Bacterial adherence is a specific interaction that plays a role in determining the organism, the host, and the site of infection. Portions of this section on bacterial adherence have been published (Schaeffer et al, 1981).
Bacterial Adhesins
UPEC expresses a number of adhesins that allow it to attach to urinary tract tissues (Mulvey, 2002). These adhesins are classified as either fimbrial or afimbrial, depending on whether the adhesin is displayed as part of a rigid fimbria or pilus (Fig. 10–5). Bacteria may produce a number of antigenically and functionally different pili on the same cell; others produce a single type; in some, no pili are seen (Klemm, 1985). A typical piliated cell may contain 100 to 400 pili. The pilus is usually 5 to 10 nm in diameter, is up to 2 µm long, and appears to be composed primarily of subunits known as pilin (Klemm, 1985). Pili are defined functionally by their ability to mediate hemagglutination of specific types of erythrocytes. The most well-described pili are types 1, P, and S.
Type 1 (Mannose Sensitive) Pili
Type 1 pili are commonly expressed on both nonpathogenic and pathogenic E. coli. Type 1 pili consist of a helical rod composed of repeating FimA subunits joined to a 3-nm wide distal tip structure containing the adhesin FimH (Jones et al, 1995). These pili mediate hemagglutination of guinea pig erythrocytes (Duguid et al, 1979). The reaction is inhibited by the addition of mannose; thus type 1 pili are termed mannose-sensitive hemagglutination (MSHA) (Svenson et al, 1984; Reid and Sobel, 1987).
The role of type 1 pili as a virulence factor in UTIs has been established. This evidence has been obtained (1) from the analysis of bacteria isolated from the urine of patients with UTIs, which were found to express mannose-sensitive (MS) adhesins (Ljungh and Wadstrom, 1983); (2) from studies with animal models (Fader and Davis, 1982; Hagberg et al, 1983a, 1983b; Iwahi et al, 1983; Hultgren et al, 1985) in which inoculation of type 1 piliated organisms into the bladder resulted in significantly more colonization of the urinary tract than inoculation of nonpiliated organisms; and (3) from the observation that anti-type 1 pili antibodies and competitive inhibitors such as methyl-α-D-mannopyranoside protected mice from contracting UTIs (Aronson et al, 1979; Hultgren et al, 1985). Recent studies have demonstrated that interactions between FimH and receptors expressed on the luminal surface of the bladder epithelium are critical for the ability of many UPEC strains to colonize the bladder and cause disease (Connell et al, 1996; Langermann et al, 1997; Thankavel et al, 1997; Mulvey et al, 1998).
P (Mannose Resistant) Pili. P pili confer tropism to the kidney, the designation “P” standing for pyelonephritis (Mulvey, 2002). P pili, which are found in most pyelonephritogenic strains of UPEC, mediate hemagglutination of human erythrocytes that is not altered by mannose and is thus termed mannose-resistant hemagglutination (MRHA) (Kallenius et al, 1979). The adhesin PapG, at the tip of the pilus, recognizes the α-D-galactopyranosyl-(1-4)-β-D-galactopyranoside moiety present in the globoseries of glycolipids (Kallenius et al, 1980; Leffler and Svanborg-Eden, 1980), which are found on P-blood group antigens and on uroepithelium (Svenson et al, 1983).
The MRHA adhesins of UPEC that do not show the digalactoside-binding specificity have been provisionally named X adhesins (Vaisanen et al, 1981). In some strains of UPEC, hemagglutination is mediated by nonpiliated adhesins or hemagglutinins (Duguid et al, 1979).
Svanborg-Eden and coworkers (1978) were the first to report a correlation between bacterial adherence and severity of UTIs. They showed that UPEC strains from girls with acute pyelonephritis had high adhesive ability whereas strains causing asymptomatic bacteriuria or from the feces of healthy girls had low bacterial adherence. Between 70% and 80% of the pyelonephritic strains, but only 10% of the bowel isolates, had adhesive capacity. Furthermore, P pili were present in 91% of urinary strains causing pyelonephritis, 19% of strains causing cystitis, and 14% of strains causing asymptomatic bacteriuria but only 7% of bowel isolates from healthy children, highlighting the correlation between bacterial adherence and UTIs (Kallenius et al, 1981).
Whereas MRHA and P pili are strongly associated with pyelonephritis, these virulence factors are not associated with renal scarring and reflux due to bacterial infection (Vaisanen et al, 1981). Studies suggest minimal correlation between P-piliated E. coli strains and recurrent pyelonephritis with gross reflux in girls (Lomberg et al, 1983). Thus it would appear that P pili in acute pyelonephritis are important mainly in nonrefluxing or minimally refluxing children.
Other Adhesins
S pili, which bind to sialic acid residues via the SfaS adhesin, have been associated with both bladder and kidney infection (Mulvey, 2002). F1C pili bind to glycosphingolipids in renal epithelial cells and induce an interleukin-8 inflammatory response (Backhed et al, 2002).
UPEC also expresses a group of afimbrial adhesins (AFA), which have been clustered with the Dr adhesin family for their recognition of decay-accelerating factor and for their similar genetic structure. Decay-accelerating factor is found on numerous different epithelial sites, and Dr adhesins are known to bind to many locations throughout the urinary tract (Anderson et al, 2004b).
Phase Variation of Bacterial Pili in Vivo
Early evidence for the role of type 1 and P pili in adherence in UTIs in humans was contradictory. Pili were visible by electron microscopy on E. coli in the urine of 31 of 37 patients (Ljungh and Wadstrom, 1983). Conversely, no MS adhesins were found in 22 of 24 urine isolates from patients with indwelling catheters (Ofek et al, 1981), and 19 of 20 samples from patients with acute UTIs were devoid of pili and nonadherent until subcultured in broth (Harber et al, 1982). Assessment of pili production by clinical E. coli isolates demonstrates that environmental growth conditions can produce rapid changes in pilus expression (Duguid et al, 1966; Goransson and Uhlin, 1984; Hultgren et al, 1986), wherein cells switch back and forth between piliated and nonpiliated phases (Eisenstein, 1981). For example, some bacteria grown in a broth medium express pili whereas the same strain grown on the same medium in a solid state will cease production of pili. This process, called phase variation, can also occur in vivo and has obvious biologic and clinical implications. For example, the presence of type 1 pili may be advantageous to the bacteria for adhering to and colonizing the bladder mucosa but disadvantageous because the pili enhance phagocytosis and killing by neutrophils (Silverblatt et al, 1979).
An animal model of ascending UTIs and studies of bacterial isolates from different sites in patients with UTI provide evidence that phase variation can occur during E. coli UTI in vivo. Type 1 piliated E. coli organisms that were capable of phase variation were introduced into the mouse bladder in the piliated phase, and the bacteria recovered from the bladder and urine 24 or more hours after inoculation were tested for piliation. All of the animals had bladder colonization, and 78% of the bacteria recovered showed type 1 piliation. The bacteriologic state of the urine often differed from that of the bladder. The urine was sterile in 59% of the animals with bladder colonization, and the organisms recovered from the urine were often nonpiliated.
When bladder and kidney cultures were examined 1, 3, and 5 days after intravesical inoculation of piliated bacteria, organisms recovered from the bladder remained piliated, whereas organisms recovered from the kidney showed significantly less piliation (Schaeffer et al, 1987) (Fig. 10–6).

Figure 10–6 Time study after intravesical inoculation with E. coli strain I-I49 that compared the mean viable bacteria count (solid circles) and hemagglutination (HA) titer (open circles) for bladders (A), kidneys (B), and urine specimens (C) from the same animals. Each point is the mean of all the animals tested. The numbers in parentheses show the proportion of animals inoculated that gave positive cultures. The HA titers were tested after 18 hours of growth on agar. The HA titer of bacteria recovered from the kidney decreased significantly by day 5 (P < .001).
(A to C, From Schaeffer AJ, Schwan WR, Hultgren SJ, Duncan JL. Relationship of type 1 pilus expression in Escherichia coli to ascending urinary tract infections in mice. Infect Immun 1987;55:373–80.)
Studies in humans using indirect immunofluorescence of fresh urine bacteria have confirmed in-vivo expression and phase variation of pili. Analysis of the urine of adults with lower UTI detected type 1 pili in 31 of 41 specimens and P pili in 6 of 18 specimens (Kisielius et al, 1989). The piliation status of the bacterial population in the urine was heterogeneous, varying from predominantly piliated to a mixture of piliated and nonpiliated cells (Fig. 10–7). Strains isolated from different sites in the urogenital tract showed variation in the state of piliation. These results demonstrate that type 1 and P pili are expressed and subject to phase variation in vivo during acute UTIs.

Figure 10–7 Phase-contrast micrograph (A) and immunofluorescence micrograph (B) of a sample stained with antiserum to type 1 pili of strain I-49 and with FITC-conjugated second antibody against nonadherent E. coli in the urine of a patient with acute UTI show a mixture of piliated and nonpiliated (arrows in B) cells.
(A and B, From Kisielius PV, Schwan WR, Amundsen SK, et al. In vivo expression and variation of Escherichia coli type 1 and P pili in the urine of adults with acute urinary tract infections. Infect Immun 1989;57:1656.)
This process of phase variation has obvious biologic and clinical implications. For example, the presence of type 1 pili may be advantageous to the bacteria for initially adhering to and colonizing the bladder mucosa. Subsequently, type 1 pili may be unnecessary for strains in suspension in urine and in fact detrimental because they enhance apoptosis, phagocytosis, and killing by neutrophils (Silverblatt et al, 1979; Mulvey et al, 1998). In the kidney, P pili may then take over as the primary mediator of bacterial attachment by means of their binding to the glycolipid receptors (Stapleton et al, 1995).
Epithelial Cell Receptivity
Vaginal Cells
The significance of epithelial cell receptivity in the pathogenesis of ascending UTI has been studied initially by examining adherence of E. coli to vaginal epithelial cells and uroepithelial cells collected from voided urine specimens. Fowler and Stamey (1977) established that certain indigenous microorganisms (e.g., lactobacilli, S. epidermidis) avidly attached themselves to washed epithelial cells in large numbers. When vaginal epithelial cells were collected from patients susceptible to reinfection and compared with such cells obtained from controls resistant to UTI, the E. coli strains that cause cystitis adhered much more avidly to the epithelial cells from the susceptible women. These studies established increased adherence of pathogenic bacteria to vaginal epithelial cells as the first demonstrable biologic difference that could be shown in women susceptible to UTI.
Subsequently, Schaeffer and colleagues (1981) confirmed these vaginal differences in women, but in addition they observed that the increased bacterial adherence was also characteristic of buccal epithelial cells. As can be seen in Figure 10–8, there is a striking similarity in the ability of both cell types to bind to the same E. coli strain. In addition, there was a significant relationship between vaginal cell and buccal cell receptivity. Seventy-seven different E. coli strains were tested for their ability to bind to vaginal and buccal epithelial cells. A direct nonlinear relationship between buccal and vaginal adherence in controls and patients was confirmed for urinary, vaginal, and anal isolates. Thus high vaginal cell receptivity was associated with high buccal cell receptivity.

Figure 10–8 In-vitro adherence of E. coli to vaginal (A) and buccal (B) cells from healthy controls and patients with recurrent UTIs. Values represent an average of 14 (A) and 11 (B) determinations in each individual. The open circles and bars represent the means + standard error of the mean.
(A and B, From Schaeffer AJ, Jones JM, Dunn JK. Association of in vitro Escherichia coli adherence to vaginal and buccal epithelial cells with susceptibility of women to recurrent urinary tract infections. N Engl J Med 1981;304:1062–6.)
These observations emphasize that the increase in receptor sites for UPEC on epithelial cells from women with recurrent UTIs is not limited to the vagina and thus suggest that a genotypic trait for epithelial cell receptivity may be a major susceptibility factor in UTIs. This concept was extended by examining the human leukocyte antigens (HLAs), which are the major histocompatibility complex in humans and have been associated statistically with many diseases (Schaeffer et al, 1983). The A3 antigen was identified in 12 (34%) of the patients, which is significantly higher than the 8% frequency observed in healthy controls. Thus HLA-A3 may be associated with increased risk of recurrent UTIs.
Variation in Receptivity
A small variation in both vaginal cell and buccal cell receptivity may be observed from day to day in healthy controls. Adherence ranges from 1 to 17 bacteria per cell and appears to be both cyclic and repetitive. When adherence was correlated with the days of a woman’s menstrual cycle, higher values were noted in the early phase, diminishing shortly after the time of expected ovulation (day 14). The number of bacteria per epithelial cell often correlated with the value obtained on the same day of the menstrual cycle 1 or 2 months previously. Premenopausal women are particularly susceptible to attachment of uropathogenic E. coli and nonpathogenic lactobacilli at certain times during the menstrual cycle and to E. coli during the early stages of pregnancy. The importance of such hormones as estrogens in the pathogenesis of UTI is therefore a matter of great interest, especially because the clinical urologist may see women who have recurrent cystitis at regular intervals, possibly in response to these hormonal changes.
Reid and Sobel (1987) found that uropathogens attached in larger numbers to uroepithelial cells from women older than 65 years of age than to cells from premenopausal women 18 to 40 years of age. Raz and Stamm (1993) noted that susceptibility to recurrent UTI was increased by the lowered estrogen levels found in the postmenopausal women and that estrogen replacement decreased uropathogenic bacterial colonization and the incidence of UTI.
Blood group antigens and carbohydrate structures bound to membrane lipids or proteins also constitute an important part of the uroepithelial cell membrane. The presence or absence of blood group determinants on the surface of uroepithelial cells may influence an individual’s susceptibility to a UTI. Sheinfeld and associates (1989) determined the blood group phenotypes in women with recurrent UTI and compared them with those of age-matched women controls. Women with Lewis Le(a−b−) and Le(a+b−) phenotypes had a significantly higher incidence of recurrent UTIs than women with Le(a−b+) phenotypes. There was no significant difference in the distribution of ABO or P blood group phenotypes. The Lewis antigen controls fucosylation. The protective effect in women with the Le(a−b+) phenotype may be due to fucosylated structures at the vaginal cell surface or in the overlying mucus, which decreases availability of putative receptors for E. coli (Navas et al, 1993). The nonsecretor status has also been associated with female acute uncomplicated pyelonephritis, especially in premenopausal women (Ishitoya et al, 2002). Stapleton and coworkers (1995) have shown that unique E. coli-binding glycerides are found in vaginal epithelial cells from nonsecretors but not from secretors. These studies individually and collectively support the concept that there is an increased epithelial receptivity for E. coli on the introital, urethral, and buccal mucosa that is characteristic of women susceptible to recurrent UTIs and may be a genotypic trait.
The possibility that vaginal mucus might influence bacterial receptivity was investigated by Schaeffer and colleagues (1994). Type 1 piliated E. coli bound to all of the vaginal fluid specimens (Venegas et al, 1995). The binding capacity of vaginal fluid from women colonized with E. coli in vivo was greater than that from noncolonized women (Schaeffer, 1999). The importance of vaginal fluid in bacteria/epithelial cell interactions was investigated in an in-vitro model that measured the effect of vaginal fluid on the binding of bacteria to an epithelial cell line (Gaffney et al, 1995). Vaginal fluid from colonized women enhanced binding of bacteria to epithelial cells. Conversely, vaginal fluid from noncolonized women inhibited adherence. Thus the vaginal fluid appears to influence adherence to cells and, presumably, vaginal mucosal colonization. Subsequent studies demonstrated that secretory IgA is the primary glycoprotein responsible for vaginal fluid receptivity (Rajan et al, 1999).
Bladder Cells
FimH binds mannosylated residues on the uroplakin molecules covering bladder superficial epithelial cells. The luminal surface of the bladder is lined by umbrella cells. The apical surfaces of umbrella cells appear as a quasi-crystalline array of hexagonal complexes composed of four integral membrane proteins known as uroplakins (Sun, 1996). In-vitro binding assays have shown that two of the uroplakins, UPIa and UPIb, can specifically bind UPEC expressing type 1 pili (Wu et al, 1996). High-resolution freeze-fracture electron microscopy has shown that the tips of these pili, including the adhesins, are buried in the central cavity of the uroplakin hexameric rings (Mulvey et al, 2000) (Fig. 10–9A). Thus fimH-mediated binding to the bladder epithelium is the initial step in the intricate cascade of events leading to UTIs.

Figure 10–9 UPEC binds, invades, and multiplies inside the superficial cells of the bladder epithelium. A, Scanning electron microscopy shows a single UPEC bound to the surface of a bladder cell. Type 1 pilus-mediated contact between bacterium and host cell initiates signaling cascades in the bladder cell, leading to localized actin rearrangements and membrane protrusions around the bacterium. Scale bar, 0.5 µm. B, Once inside the bladder superficial cells, UPEC rapidly multiplies to form disordered bacterial clusters in the host cell cytoplasm, called an early intracellular bacterial community (IBC). Bacteria are visible as dark-staining rods inside the cell in this hematoxylin and eosin (H&E)-stained thin bladder section. Scale bar, 100 µm. C, H&E-stained thin bladder section reveals a middle IBC, wherein the constituent bacteria have organized themselves into a biofilm-like state within the bladder cell. Scale bar, 20 µm. D, A late IBC, visible by H&E staining, is typified by detachment of peripheral bacteria and fluxing of these organisms into the bladder lumen. Scale bar, 10 µm.
(From Anderson GG, Martin SM, Hultgren SJ. Host subversion by formation of intracellular bacterial communities in the urinary tract. Microbes Infect 2004;6:1094–1101.)
UPEC Persistence in the Bladder
Soon after attachment to the epithelium, UPEC is quickly internalized into the bladder superficial cells (Martinez and Hultgren, 2002; Anderson et al, 2004b) (Fig. 10–9B). FimH is essential for UPEC invasion; isogenic fimH-mutants do not invade, and invasion of wild-type bacteria can be inhibited by the addition of mannose. In addition, polystyrene latex beads coated with fimH are quickly internalized in a process identical to bacteria expressing type 1 pili. This process is the result of localized actin rearrangement and engulfment of the bound bacterium by zippering of the membrane around the microorganism (Martinez and Hultgren, 2002). Invasion into the superficial epithelium of the bladder allows UPEC to establish a new niche in an effort to protect itself from the host innate immune response (Anderson et al, 2004b).
Once intracellular, the UPEC organisms rapidly grow and divide within the cell cytosol, forming small clusters of bacteria termed early intracellular bacterial communities (IBCs) (Anderson et al, 2004b; Justice et al, 2004). As they grow, the bacteria maintain their typical rod shape of approximately 3 µm and form a loosely organized cluster, with microorganisms randomly oriented in the cell cytoplasm. Between 6 to 8 hours after inoculation, early IBCs show a drop in bacterial growth rate resulting in doubling times greater than 60 minutes, a significant shortening of the bacterial morphology to an average of 0.7 µm, and a phenotypic switch into a biofilm-like community (Justice et al, 2004) (see Fig 10–9C).
Biofilms shield bacteria from environmental challenges such as antimicrobial agents and the host immune response (Donlan and Costerton, 2002). Characteristics of the biofilm that increase protection include the slower growth rate of the bacteria with associated physiologic changes, expression of factors that inhibit antimicrobial activity, and the inability of the antimicrobial agent to penetrate the biofilm matrix (Anderson et al, 2004b). The biofilm also protects the bacteria from neutrophils because they are unable to effectively penetrate the IBC and engulf the bacteria. In animal models, bacteria on the edge of IBCs eventually detach, differentiate to typical rod morphology, become motile, and then escape the host cell into the bladder lumen in a process called fluxing (Mulvey et al, 2001) (see Fig. 10–9D). These bacteria may become highly filamentous, reaching up to 70 µm or greater in length. This process occurs by approximately 24 hours after inoculation (Justice et al, 2004). It is possible that the filaments may help the bacteria evade the immunologic response.
The escaped bacteria readhere and reinvade superficial cells to lead to second IBC formation. In subsequent rounds, further IBC formation occurs. After a few days, the invasive bacteria become more quiescent. In animal models, the bacteria can persist in this dormant reservoir state for some time before reemerging to cause recurrent UTIs (Anderson et al, 2004a).
Natural Defenses of the Urinary Tract
Periurethral and Urethral Region
The normal flora of the vaginal introitus, the periurethral area, and the urethra usually contain microorganisms such as lactobacilli, coagulase-negative staphylococci, corynebacteria, and streptococci that form a barrier against uropathogenic colonization (Fair et al, 1970; Pfau and Sacks, 1977; Marrie et al, 1978). Changes in the vaginal environment related to estrogen, cervical IgA (Stamey et al, 1978), and low vaginal pH (Stamey and Timothy, 1975) may alter the ability of these bacteria to colonize. More commonly, however, acute changes in colonization have been associated with use of antimicrobial agents and spermicidal agents that alter the normal flora and increase the receptivity of the epithelium for uropathogens.
Little is known about the factors that predispose patients to urethral colonization with uropathogens. The proximity of the urethral meatus to the vulvar and perianal areas suggests that contamination occurs frequently. The nature of urethral defense mechanisms other than flow of urine is largely unknown. Bacterial multiplication in the normal urethra may be inhibited by the indigenous flora (Chan et al, 1984). Although colonization of the periurethral and urethral regions is prerequisite to most infections, the ability of the organisms to overcome the normal defense mechanisms of the urine and the bladder is clearly pivotal.
Urine
In general, fastidious organisms that normally colonize the urethra will not multiply in urine and rarely cause UTIs (Cattell et al, 1974). In contrast, urine will usually support the growth of nonfastidious bacteria (Asscher et al, 1968). Urine from normal individuals may be inhibitory, especially when the inoculum is small (Kaye, 1968). The most inhibitory factors are the osmolality, urea concentration, organic acid concentration, and pH. Bacterial growth is inhibited by either very dilute urine or a high osmolality when associated with a low pH. Much of the antimicrobial activity of urine is related to a high urea and organic acid content (Solomon et al, 1983). From a clinical perspective, however, these conditions do not appear to significantly distinguish between patients who are susceptible or resistant to infection.
Uromodulin (Tamm-Horsfall protein), a kidney-derived mannosylated protein that is present in an extraordinarily high concentration in the urine (greater than 100 mg/mL), may play a defensive role by saturating all the mannose-binding sites of the type 1 pili, thus potentially blocking bacterial binding to the uroplakin receptors of the urothelium (Duncan, 1988; Kumar and Muchmore, 1990).
Bladder
Bacteria presumably make their way into the bladder fairly often. Whether small inocula of bacteria persist, multiply, and infect the host depends in part on the ability of the bladder to empty (Cox and Hinman, 1961). Additional factors responsible for defense involve both innate and adaptive immunity and exfoliation of epithelial cells.
Immune Response
Pathogen Recognition
The host recognition of the pathogen is mediated by a series of pathogen-associated molecular pattern receptors (PAMPs), such as Toll-like receptors (TLRs) (Anderson et al, 2004b), which provide the link between recognition of invading organisms and development of the innate immune response. TLRs recognize molecular patterns that are conserved among many species of pathogens, such as lipopolysaccharide (LPS) and peptidoglycan (PG), and activate signaling pathways that initiate immune and inflammatory responses to kill pathogens. Superficial bladder epithelial cells express TLR4 on their membranes, which along with CD14 recognize LPS from the bacteria and activate the innate immune response (Anderson et al, 2004a). The newly identified TLR11, which recognizes UPEC and protects the kidneys from ascending infection, is also expressed on uroepithelial cells as well as renal cells (Zhang et al, 2004).
The innate system response to an infection in the bladder or kidneys is primarily local inflammation.
The innate immune response occurs more rapidly than the adaptive response and involves a variety of cell types, including polymorphonuclear leukocytes, neutrophils, macrophages, eosinophils, natural killer cells, mast cells, and dendritic cells. In addition, increased transcription of inducible nitric oxide synthase by polymorphonuclear leukocytes results in high levels of nitric oxide and related breakdown products that also have toxic effects on the bacteria (Poljakovic et al, 2001; Poljakovic and Persson, 2003). The innate response aids in establishing adaptive immunity due to interactions of macrophages, dendritic cells, and natural killer cells with T and B lymphocytes. Adaptive immunity involves the specific recognition of pathogens by T and B lymphocytes and production of high-affinity antibodies, a process that occurs 7 to 10 days after infection.
The urinary tract is part of the secretory immune system. In pyelonephritis, IgG and SIgA appear in the urine and may become evident before antibodies are detected in the serum. These antibodies are synthesized locally within the kidney and may enhance bacterial opsonization and ingestion by local phagocytic cells. These antibodies may have further protective function. Svanborg-Eden and Svennerholm (1978) showed that IgG and SIgA derived from the urine of patients with acute pyelonephritis reduced in-vitro adherence of the same strain of E. coli to uroepithelial cells. Similarly, immunization with E. coli P pili resulted in immunoglobulin production in experimental animals that prevented ascending pyelonephritis by reducing the adhesive capacity of the invading autologous uropathogenic E. coli (Roberts and Phillips, 1979; O’Hanley, 1983).
The possibility that immunologic factors may be modified to reduce susceptibility to infection has been explored primarily through immunization in animal and human systems. For example, in a monkey model, vaccination with P fimbria has been shown to reduce adherence of P-fimbriated E. coli to uroepithelial cells and prevent acute pyelonephritis (Roberts and Phillips, 1979). Similarly, vaccination of mice with FimH adhesin prevents cystitis in mice (Langermann et al, 1997). Vaccination of women may reduce colonization of the vaginal introitus and subsequent ascending bacteria (Uehling et al, 1994).
Induced Exfoliation
Mulvey and colleagues (1998) demonstrated that exfoliation and excretion of infected and damaged superficial cells is mediated by type 1 piliated bacteria that induce programmed cell death. By utilizing an in-vivo mouse model, it has been demonstrated that mice exhibiting a strong exfoliation response to UPEC infiltration are unlikely to form IBCs (Anderson et al, 2004b). However, mice with a much milder exfoliation response tend to form biofilms, which become sequestered in the bladder and presumably could lead to recurrent UTIs. It has also been shown that many uropathogenic bacteria can suppress NFκB, increase apoptosis, and decrease the inflammatory responses (Klumpp et al, 2001), a process that could lead to subsequent bacterial invasion into deeper tissues. Thus in some instances apoptosis may be a bacterial offense maneuver rather than a host defense.
Alterations in Host Defense Mechanisms
Obstruction
Obstruction to urine flow at all anatomic levels is a key factor in increasing host susceptibility to UTI. Obstruction inhibits the normal flow of urine, and the resulting stasis compromises bladder and renal defense mechanisms. Stasis also contributes to the growth of bacteria in the urine and their ability to adhere to the urothelial cells. In the animal model of experimental hematogenous pyelonephritis the kidney is relatively resistant to infection unless a ureter is ligated. Under these circumstances only the obstructed kidney becomes infected (Beeson and Guze, 1956). Clinical observations support the role of obstruction in pathogenesis of UTI and in increasing severity of infection. Mild episodes of cystitis or pyelonephritis can become life threatening when obstruction to urine flow becomes present. Although obstruction clearly increases the severity of infection, it need not be a predisposing factor. For example, men with large residual urine may remain uninfected for years. However, if they are catheterized, even small inocula may lead to severe infections that are difficult to eradicate.
Vesicoureteral Reflux
Hodson and Edwards (1960) first described the association of vesicoureteral reflux, UTI, and renal clubbing and scarring. Children with gross reflux and UTIs usually develop progressive renal damage manifested by renal scarring, proteinuria, and renal failure. Those with a lesser degree of reflux usually improve or completely recover spontaneously or after treatment of the UTI. In adults, the presence of reflux does not appear to decrease renal function unless there is stasis and concurrent UTIs.
Underlying Disease
There is a high incidence of renal scarring in patients with underlying conditions that cause chronic interstitial nephritis, virtually all of which produce primary renal papillary damage. These conditions include diabetes mellitus, sickle cell disorders, adult nephrocalcinosis, hyperphosphatemia, hypokalemia, analgesic abuse, sulfonamide nephropathy, gout, heavy-metal poisoning, and aging (Freedman, 1979).
Diabetes Mellitus
An increased incidence of clinical asymptomatic and symptomatic UTIs appears to occur in women with diabetes mellitus, but there is no substantial increase among diabetic men (Vejlsgaard, 1973; Ooi et al, 1974; Forland et al, 1977; Meiland et al, 2002). Diabetes also results in three times more hospitalizations for acute pyelonephritis among women (10.86/10,000) than for men (3.32/10,000) (Nicolle et al, 1996). Autopsy studies have shown the incidence of pyelonephritis to be fourfold to fivefold higher in diabetic than in nondiabetic individuals (Robbins and Tucker, 1944). However, such studies may be misleading because it is difficult to distinguish renal parenchymal changes resulting from pyelonephritis from the interstitial inflammatory changes of diabetic nephropathy.
Although most UTIs in diabetic patients are asymptomatic, diabetes appears to predispose the patient to more severe infections. There is no evidence that increased frequency of infection is due to glycosuria (Geerlings et al, 2000). One study using antibody-coated bacteria techniques to localize the site of infection showed the upper urinary tract to be involved in nearly 80% of diabetic patients with UTIs (Forland et al, 1977). This evidence of increasing immunologic response in diabetic patients who acquire bacteriuria suggests renal parenchymal involvement and a potential increase in morbidity.
Infections are frequently caused by atypical organisms such as yeast and result in upper tract infections and significant sequelae such as emphysematous pyelonephritis, papillary necrosis, perinephric abscess, or metastatic infection (Wheat, 1980; Stapleton, 2002).
Renal Papillary Necrosis
The role of infection in the development and progression of renal papillary necrosis (RPN) is controversial. Multiple predisposing conditions have been associated with the development of RPN, particularly diabetes, analgesic abuse, sickle cell hemoglobinopathy, and obstruction (Table 10–2).
Table 10–2 Conditions Associated with Renal Papillary Necrosis
From Eknoyan G, Qunibi WY, Grissom RT, et al. Renal papillary necrosis: an update. Medicine 1982;61:55.
Clinically, RPN is a spectrum of disease. Patients may have an acute fulminating illness with rapid progression or may have a chronic disease that is incidentally discovered. Some patients may chronically pass necrotic tissue in their urine (Hernandez et al, 1975), and some may never pass papillae (Lindvall, 1978). Retained necrotic papillae may calcify, especially in association with infection. Furthermore, this necrotic tissue may form the nidus for chronic infection. Opportunistic fungal infections have been reported (Madge and Lombardias, 1973; Juhasz et al, 1980; Vordermark et al, 1980; Tomashefski and Abramowsky, 1981). Renal ultrasonography may be useful to diagnose RPN (Buonocore et al, 1980; Hoffman et al, 1982).
The early diagnosis of RPN is important to improve prognosis and reduce morbidity. In addition to chronic infection, patients with analgesic abuse–associated papillary necrosis may have an increased incidence of urothelial tumors; routine urinary cytologic examinations may be helpful to diagnose these tumors early (Jackson et al, 1978). In patients who have analgesic abuse–induced RPN, the disease stabilizes if the analgesic intake is stopped (Gower, 1976). Furthermore, adequate antimicrobial therapy to control infection and early recognition and treatment of ureteral obstruction caused by sloughed necrotic tissue can minimize a decline in renal function. A patient who suffers from an acute ureteral obstruction due to a sloughed papilla and who has a concomitant UTI has a urologic emergency. In this case, immediate removal of the obstructing papilla by stone basket (Jameson and Heal, 1973) or acute drainage of the kidney by ureteral catheter or percutaneous nephrostomy is necessary.
Other conditions that may increase the susceptibility of the kidney to infection include hypertension and vascular obstruction (Freedman, 1979). Association of renal infection with several other renal diseases, including glomerulonephritis, atherosclerosis, and tubular necrosis, which are not associated with papillary necrosis, does not lead to pyelonephritis and scarring.
Human Immunodeficiency Virus
UTIs are fivefold more prevalent in HIV-positive individuals than in control subjects (Schonwald et al, 1999). Furthermore, the pathologic flora are more reminiscent of complicated UTIs. It also appears that HIV-positive patients with UTIs have a tendency for recurrence and require longer treatment.
Pregnancy
The prevalence of bacteriuria in pregnant women varies from 4% to 7%, and the incidence of acute clinical pyelonephritis ranges from 25% to 35% in untreated bacteriuric women (Stamey, 1980). This is probably the result of dilation of the ureters and pelvis of the kidney secondary to pregnancy-related hormonal alterations. In addition, urine obtained from pregnant women exhibits a more suitable pH for growth of E. coli in all stages of gestation (Asscher et al, 1973). It is not surprising that untreated bacteriuria in the first trimester is accompanied by a substantial increase in the incidence of acute pyelonephritis, because half of these women have upper tract bacteriuria (Fairley et al, 1966). Untreated bacteriuria involving these dilated upper tracts would be expected to produce a significant number of abnormalities that should be radiologically apparent. Kincaid-Smith and Bullen (1965) performed a culture on 4000 women at their first antenatal visit. Of 240 bacteriuric women, 148 returned for excretory urography 6 weeks after delivery. Approximately 40% of these patients had radiologic abnormalities consistent with pyelonephritis or analgesic nephritis. Brumfitt and colleagues (1967) showed that the incidence of radiologic abnormalities in bacteriuria of pregnancy was proportional to the difficulty in clearing the infection. Patients who responded promptly to a single course of therapy had a 23% incidence of radiologic abnormalities, but those who remained bacteriuric despite repeated therapeutic efforts had a 65% incidence of radiologic changes. Thus prolonged bacteriuria and pyelonephritis of pregnancy appear to be associated with significant radiologic abnormalities. However, there is little evidence to suggest that bacteriuria of pregnancy or acute pyelonephritis of pregnancy causes these renal radiologic abnormalities.
Spinal Cord Injury with High-Pressure Bladders
Of all patients with bacteriuria, no group compares in severity and morbidity with those who have spinal cord injury. Nearly all these patients require catheterization early after their injuries because of bladder overactivity or flaccidity, and significant numbers develop ureterectasis, hydronephrosis, reflux, and renal calculi. Bacteriologic and urodynamic advances in the management of these patients have vastly reduced their morbidity and mortality. Special problems associated with spinal cord injury are presented in a later section.
Clinical Manifestations
Symptoms and Signs
Cystitis is usually associated with dysuria, frequency, and/or urgency. Suprapubic pain and hematuria are less common. Lower tract symptoms are commonly present and usually predate the appearance of upper tract symptoms by several days. Pyelonephritis is classically associated with fever, chills, and flank pain. Nausea and vomiting may be present. Renal or perirenal abscess may cause indolent fever and flank mass and tenderness. In the elderly the symptoms may be much more subtle (e.g., epigastric or abdominal discomfort) or the patient may be asymptomatic (Romano and Kaye, 1981). Patients with indwelling catheters often have asymptomatic bacteriuria, but fever associated with bacteremia may occur rapidly and become life threatening.
Diagnosis
Presumptive diagnosis of UTI is made by direct or indirect analysis of the urine and is confirmed by urine culture. The urine and the urinary tract are normally free of bacteria and inflammation. False-negative urinalysis and culture can occur in the presence of UTI, particularly early in an infection when the numbers of bacteria and WBCs are low or diluted by increased fluid intake and subsequent diuresis. Occasionally, the urine may be free of bacteria and WBCs despite bacterial colonization and inflammation of the uroepithelium (Elliott et al, 1985; Hultgren et al, 1985). False-positive urinalysis and culture are caused by contamination of the urine specimen with bacteria and WBCs during collection. This is most likely to occur in voided specimens but can also occur during urethral catheterization. Suprapubic aspiration of bladder urine is least likely to cause contamination of the specimen; therefore it provides the most accurate assessment of the status of bladder urine.
Urine Collection
Voided and Catheterized Specimens
Diagnostic accuracy can be improved by reducing bacterial contamination when the urine is collected. In circumcised men, voided specimens require no preparation. For men who are not circumcised, the foreskin should be retracted and the glans penis washed with soap and then rinsed with water before specimen collection. The first 10 mL of urine (representative of the urethra) and a midstream specimen (representative of the bladder) should be obtained. Prostatic fluid is obtained by performing digital prostatic massage and collecting the expressed prostatic fluid on a glass slide. In addition, collection of the first 10 mL of voided urine after massage will reflect the prostatic fluid added to the urethral specimen. Catheterization of a male patient for urine culture is not indicated unless the patient cannot urinate.
In women, contamination of a midstream urine specimen with introital bacteria and WBCs is common, particularly when the woman has difficulty spreading and maintaining separation of the labia. Therefore the female should be instructed to spread the labia, wash and cleanse the periurethral area with a moist gauze, and then collect a midstream urine specimen. Cleansing with antiseptics is not recommended because they may contaminate the voided specimen and provide a false-negative urine culture. The voided specimen is contaminated if it shows evidence of vaginal epithelial cells and lactobacilli on urinalysis, and a catheterized specimen should be collected.
Catheterization and collection of a midcathterized specimen is more accurate than a voided specimen but carries a risk of iatrogenic infection. Although a single dose of an oral antimicrobial agent, such as trimethoprim-sulfamethoxazole (TMP-SMX) may be effective for prophylaxis, because antimicrobial usage encourages development of bacterial resistance, prophylaxis should be limited to high-risk patients. Men should be catheterized for a urine culture if they cannot urinate.
Suprapubic Aspiration
Suprapubic aspiration is highly accurate, but because it carries some morbidity there is limited clinical usefulness except for a patient who cannot urinate on command, such as patients with spinal cord injuries. It is highly useful in newborns (Newman et al, 1967) and in patients with paraplegia. A single aspirated specimen reveals the bacteriologic status of the bladder urine without introducing urethral bacteria, which can start a new infection.
Before a suprapubic aspiration is performed, the patient should force fluids until the bladder is full. The site of the needle puncture is in the midline, between the symphysis pubis and the umbilicus and directly over the palpable bladder. The full bladder in the male is usually palpable because of its greater muscle tone; unfortunately, the full bladder in the female is frequently not palpable. In such patients, the physician performing the aspiration must rely on the observation that suprapubic pressure directly over the bladder produces an unmistakable desire to urinate. After determining the approximate site for needle puncture, the local area is shaved and the skin is cleansed with an alcohol sponge; a cutaneous wheal is raised with a 25-gauge needle and any local anesthetic. A 3.5-inch spinal, 22-gauge needle is introduced through the anesthetized skin. The progress of the needle is arrested just below the skin within the anesthetized area, and with a quick plunging action, similar to that of any intramuscular injection, the needle is advanced into the bladder. Most patients experience more discomfort from the initial anesthetization of the skin than they feel during the second stage when the needle is advanced into the bladder. After the needle has been introduced, a 20-mL syringe is used to aspirate 5 mL of urine for culture and 15 mL of urine for centrifugation and urinalysis. The obturator is reintroduced into the needle, and both needle and obturator are withdrawn. A small dressing is placed over the needle site in the skin. If urine is not obtained with complete introduction of the needle, the patient’s bladder is not full and is usually deep within the retropubic area. When no urine is obtained on the first attempt, it is probably wise to wait until the bladder is full.
Urinalysis
For patients with urinary symptoms, microscopic urinalysis for bacteriuria, pyuria, and hematuria should be performed. Urinalysis provides rapid identification of bacteria and WBCs and presumptive diagnosis of UTI. Usually, the sediment from a 5- to 10-mL specimen obtained by centrifugation for 5 minutes at 2000 rpm is analyzed. Microscopic bacteriuria is found in more than 90% of infections with counts of 105 colony-forming units (cfu) per milliliter of urine or greater and is a highly specific finding (Stamm, 1982; Jenkins et al, 1986). However, bacteria are usually not detectable microscopically with lower colony count infections (102 to 104/mL). This important error (i.e., a false-negative result) occurs because of the limitation imposed by the microscope on the volume of urine that can be observed. If the volume of urine that can easily rest beneath a standard 22-mm cover glass is carefully measured (0.01 mL) and the number of high dry fields (×570 magnification) present beneath the cover glass is estimated, it is disturbing to find that one high dry field represents a volume of approximately 1/30,000 mL. There are excellent studies showing that the bacterial count must be approximately 30,000/mL before bacteria can be found in the sediment, stained or unstained, spun or unspun (Sanford et al, 1956; Kunin, 1961). For these reasons, a negative urinalysis for bacteria never excludes the presence of bacteria in numbers of 30,000/mL and less.
The second error of urinalysis (i.e., a false-positive result) is the reverse of the first error: bacteria are seen in the microscopic sediment but the urine culture shows no growth. The voided urine from a female patient can contain many thousands of lactobacilli and corynebacteria. These bacteria are readily seen under the microscope; and although they are gram-positive, they often appear gram-negative (gram-variable) if stained. Strict anaerobes, usually gram-negative bacilli, also make up a significant mass of the normal vaginal flora (Marrie et al, 1978).
In practice, these problems can be minimized by using other information provided by urinalysis that can help the clinician to decide whether a patient has a UTI (Stamm et al, 1982b). The validation of the midstream urine specimen can be questioned if numerous squamous epithelial cells (indicative of preputial, vaginal, or urethral contaminants) are present.
Pyuria and hematuria are good indicators of an inflammatory response. Although the number of WBCs per high-power field in a centrifuged urine sample is useful, it is important to remember that other factors can influence the number of cells seen. These include the state of hydration; the intensity of tissue reaction; the method of urine collection; the volume, speed, and time of centrifugation; and the volume in which the sediment is resuspended.
The presence of bacteruria has a sensitivity of 40% to 70% and a specificity of 85% to 95%, depending on the number of bacteria observed (Fihn, 2003).
Significant pyuria can be determined simply and reliably with a microscope by accurately examining the centrifuged sediment or by using a hemocytometer to count the number of WBCs in the unspun urine. One to 2 WBCs per high-power field (HPF) in sediment from a centrifuged specimen represents about 10 WBCs/mm3 in an unspun specimen. More than 2 WBCs per HPF in a centrifuged specimen or 10 WBCs/mm3 of urine correlates well with the presence of bacteriuria and is rarely seen in nonbacteriuric patients (Stamm et al, 1981). In clinical studies, determination of pyuria in voided urine specimens has a reported sensitivity of 80% to 95% and a specificity of 50% to 76% for UTI (depending on the definition of infection, the patient population, and the method used to evaluate for pyuria) (Stamm, 1982; Schultz et al, 1984; Wong et al, 1984; Wigton et al, 1985).
The absence of pyuria should cause the diagnosis of UTI to be questioned until urine culture data are available. Conversely, many diseases of the urinary tract produce significant pyuria in the absence of bacteriuria. Whereas tuberculosis is the well-recognized example of abacterial pyuria, staghorn calculi and stones of smaller size can produce intense pyuria with clumps of WBCs in the absence of UTI. Almost any injury to the urinary tract, from chlamydial urethritis to glomerulonephritis and interstitial cystitis, can elicit large numbers of fresh polymorphonuclear leukocytes (glitter cells). Depending on the stage of hydration, the intensity of the tissue reaction producing the cells, and the method of urine collection, any number of WBCs can be seen in the microscopic sediment in the presence of an uninfected urinary tract.
Microscopic hematuria is found in 40% to 60% of cases of cystitis and is uncommon in other dysuric syndromes (Stamm et al, 1980b; Wigton et al, 1985).
Rapid Screen Methods
Biochemical and enzymatic tests have been devised to detect bacteriuria and pyuria (Pezzlo, 1988). The Griess test detects the presence of nitrite in urine that is formed when bacteria reduce the nitrate normally present in urine. Tests for detecting pyuria by determining leukocyte esterase activity have also been developed (Chernow et al, 1984). In a study comparing traditional urine culture with these indirect tests, the combination of nitrite and leukocyte esterase tests (either test positive) had a sensitivity of 71% and a specificity of 83% when compared with 103 cfu/mL or greater of urine cultures (Pfaller and Koontz, 1985). However, several investigators (Pels et al, 1989; Hurlbut and Littenberg, 1991) noted substantial variability in the sensitivity and specificity results, which could be markedly influenced by the types of patients and infections chosen to evaluate the tests. This concept of spectrum bias was illustrated by a study that reported differences in the sensitivity of reagent strip testing, ranging from 56% to 92%, by changing only the groups of patients included in the analysis. Although false-positive results are relatively uncommon, the borderline sensitivity of these tests, especially among patients with less characteristic symptoms of UTIs, does not allow these inexpensive tests to replace careful microscopic urinalysis in symptomatic patients (Semeniuk and Church, 1999). Their main role is in screening asymptomatic patients (Pezzlo, 1988).
Urine Culture
Two techniques for urine culture are available. Direct surface plating of a known amount of urine on split-agar disposable plates is the traditional quantitative culture technique used by most microbiology laboratories. One half of the plate is blood agar, which grows both gram-positive and gram-negative bacteria, and the other is desoxycholate or eosin-methylene blue (EMB), which grows gram-negative bacteria (some of them, such as E. coli, in a very characteristic manner). Simple curved-tip eye droppers are sufficient to deliver about 0.1 mL of urine onto each half of the plate. After overnight incubation, the number of colonies is estimated, often identified (after some experience), and multiplied by 10 to report the number of cfu per milliliter of urine. The technique has been presented elsewhere in detail (Stamey, 1980).
A simpler but somewhat less accurate technique is the use of dip slides (Fig. 10–10). These inexpensive plastic slides are attached to screw-top caps; they have soy agar (a general nutrient agar to grow all bacteria) on one side and EMB or MacConkey agar for gram-negative bacteria on the opposite side. A slide is dipped into urine, the excess is allowed to drain off, and the slide is replaced in its plastic bottle and incubated. The volume of urine that attaches to the slide is between 1/100 mL and 1/200 mL. Hence, the colony count is 100 to 200 times the number of colonies that become visible with incubation. In actual practice, the growth is compared with a visual standard and reported as such. The species of bacteria is more difficult to recognize when this technique is used, but the technique is completely adequate.
Figure 10–10 The dip slide on the left is compared with a split-agar surface plate on the right. The urine contained 10,000 colonies of Klebsiella per milliliter (about 200 times the number of colonies on the dip slide and 10 times the number on either side of the split-agar plate).
The urine must be refrigerated immediately on collection and should be cultured within 24 hours of refrigeration. One advantage to the dip slide is the ease with which the urine can be immediately cultured without the necessity of refrigeration. Patients can culture their own urine at home, keep the slide at room temperature, and bring it to the office within 48 hours.
Although most bacteria allowed to incubate for several hours in bladder urine reach cfu counts of 105/mL, this statistical number is fraught with two limitations. The first is that 20% to 40% of women with symptomatic UTIs present with bacteria counts of 102 to 104 cfu/mL of urine (Stamey et al, 1965; Mabeck, 1969; Kunz et al, 1975; Kraft and Stamey, 1977), probably because of the slow doubling time of bacteria in urine (every 30 to 45 minutes) combined with frequent bladder emptying (every 15 to 30 minutes) from irritation. Thus, in dysuric patients, an appropriate threshold value for defining significant bacteriuria is 102 cfu/mL of a known pathogen (Stamm and Hooton, 1993). Fortunately, most of these patients have symptoms of UTI and pyuria on urinalysis.
The second limitation of the 105 cutoff is overdiagnosis. Women susceptible to infection often carry large numbers of pathogenic bacteria on the perineum that contaminate otherwise sterile bladder urine. Uncircumcised men may harbor uropathogenic bacteria on their foreskins. In the original studies by Kass (1960), a single culture of 105 cfu/mL or more had a 20% chance of representing contamination. There is no statistical way to avoid these two major limitations on the interpretation of the midstream voided culture in women and in uncircumcised men without careful preparation.
Localization
Kidney
Fever and Flank Pain
Fever and flank pain are thought to indicate pyelonephritis, but few studies have tested the hypothesis. Aggressive localization studies in children and adults (Huland and Busch, 1982; Busch and Huland, 1984), as well as in patients with end-stage renal disease (Huland et al, 1983), have shown substantial incidences of fever and even flank pain in bacteriuric patients in whom infection was localized to the bladder (see later section on Acute Pyelonephritis).
Ureteral Catheterization
Ureteral catheterization allows not only separation of bacterial persistence into upper and lower urinary tracts but also separation of the infection between one kidney and the other, and even localization of infection to ectopic ureters or to nonrefluxing ureteral stumps (by using saline solution irrigation) (Stamey, 1980).
Stamey began in 1959 to localize the site of bacteriuria by ureteral catheterization studies; the technique was published in 1963 (Stamey and Pfau, 1963) and the results in 1965 (Stamey et al, 1965). The technique is simple but exacting; the urologist should consult a more detailed description (Stamey, 1980) before actually performing this localization technique. The validity depends on controlling the number of bacteria from the bladder that contaminate the ureteral catheters as they pass through the bladder into the ureteral orifices. The bladder must be thoroughly irrigated before both ureteral catheters are passed into a small volume of residual irrigating fluid. A sample is obtained through both ureteral catheters simultaneously, and then each catheter is passed into the ureter or renal pelvis. Four serial cultures are obtained from each kidney. It is mandatory that the patient be started on the appropriate antimicrobial agent before leaving the cystoscopy room. In addition to quantitative bacterial counts on each specimen, determination of either specific gravity or urine creatinine levels on the renal samples can be very helpful in interpreting a change in diuresis in relation to bacterial counts. Examples of infections localized to the bladder, to one kidney, and to both kidneys have been published (Stamey, 1980). Clinical examples of results from each site are shown in Table 10–3.
Table 10–3 Clinical Examples of Ureteral Catheterization Studies in Localizing the Site of Bacteriuria

When this technique was applied to large numbers of bacteriuric patients, 45% were found to have bladder infection only; 27%, unilateral renal bacteriuria; and 28%, bilateral renal bacteriuria (Table 10–4) (Stamey et al, 1965). These figures have been confirmed by at least five investigators in three countries (the United States, England, and Australia) and can be taken as a good approximation for any general bacteriuric adult population. Although renal stones and other kidney abnormalities in the presence of bacteriuria can increase the proportion of renal infections, the urologist should never assume the kidney is involved if an important decision is to be made.
Tissue and Stone Cultures
It is clinically useful to culture stones removed from the urinary tract to document that bacteria reside within their interstices. Tissue cultures are primarily useful for research information.
Using sterile technique at the operating table, the surgeon places the stone or fragment of tissue into a sterile culture tube containing 5 mL of saline solution; the culture is packed in ice and sent to the bacteriologic laboratory, where, after agitation of the stone or tissue in the 5 mL of saline solution, 0.1 mL is surface-streaked on both blood agar and EMB agar. The saline solution is then poured off the specimen; and, with sterile forceps, the stone or tissue is transferred to a second 5 mL of sterile saline solution. After agitation to ensure a reasonable washing action, the saline solution is again decanted and the specimen is transferred to a third 5 mL of saline solution and finally to a fourth 5 mL of saline solution. This last saline solution wash is cultured quantitatively in the same manner as the first. The remainder of this fourth 5 mL of saline solution is poured with the stone into a sterile mortar and pestle dish.
After the stone is crushed (or the tissue is ground in a tissue blender) in the fourth saline solution wash, 0.1 mL is again cultured on both blood agar and EMB agar. The difference in colony counts between the first and the fourth saline solution washes represents the washing effect of the saline solution transfers on the surface bacteria of the stone or tissue. The difference between the fourth saline wash before and after crushing (or grinding, for tissue) represents the difference between surface bacteria and bacteria within the specimen.
Prostate and Urethral Localization Studies
The technique for localizing infections to the urethra or prostate is covered in detail in Chapter 11.
Imaging Techniques
Imaging studies are not required in most cases of UTI because clinical and laboratory findings alone are sufficient for correct diagnosis and adequate management of most patients. However, infection in most men or a compromised host, febrile infections, signs or symptoms of urinary tract obstruction, failure to respond to appropriate therapy, and a pattern of recurrent infections suggesting bacterial persistence within the urinary tract warrant imaging for identification of underlying abnormalities that require modification of medical management or percutaneous or surgical intervention.
Indications
Radiologic studies are unnecessary for evaluation of most women with genitourinary infections. Several reports of women patients with recurrent UTIs show that excretory urograms are unnecessary for routine evaluation if women who have special risk factors are excluded (Fair et al, 1979; Engel et al, 1980; Fowler and Pulaski, 1981; Fairchild et al, 1982). In none of these studies was information that was useful in the management of these patients obtained from excretory urograms. Furthermore, excluding excretory urograms in the routine evaluation of such patients represents a substantial financial saving.
However, in high-risk patients, including women with febrile infections and most men, radiologic studies may determine acute infectious processes that require further intervention or may find the cause of complicated infections.
First, radiologic procedures are needed in patients with risk factors that may require intervention in addition to antimicrobial treatment (Table 10–5).
Table 10–5 Indications for Radiologic Investigation in Acute Clinical Pyelonephritis
|
Papillary necrosis (e.g., patients with sickle cell anemia, severe diabetes mellitus, analgesic abuse)
|
A UTI associated with possible urinary tract obstruction must be evaluated. These are patients with calculi, especially infection (struvite) stones; ureteral tumors; ureteral strictures; congenital obstructions; or previous genitourinary surgery, such as ureteral reimplantation or urinary diversion procedures that may have caused obstruction. Patients with diabetes mellitus can develop special complications from UTIs; they may acquire emphysematous pyelonephritis or papillary necrosis. Impacted necrotic papillae may cause acute ureteral obstruction. Patients with polycystic kidney disease who are on dialysis are particularly prone to developing perinephric abscesses.
Urologic imaging is indicated in patients whose symptoms of acute clinical pyelonephritis persist after 5 to 6 days of appropriate antimicrobial therapy; they often have perinephric or renal abscesses. In addition, patients with unusual organisms, including urea-splitting organisms (e.g., Proteus species), should be examined for abnormalities within the urinary tract, such as obstructing stones, strictures, or fungus balls.
The second reason for radiologic evaluation is to diagnose a focus of bacterial persistence. In patients whose bacteriuria fails to resolve after appropriate antimicrobial therapy or who have rapid recurrence of infection, abnormalities that cause bacterial persistence should be sought. Although these patients are uncommon, it is important to identify them because they may have correctable urologic abnormalities that represent the only surgically curable causes of recurrent UTIs. Acquired or congenital urologic abnormalities that can cause unresolved or recurrent UTIs are listed in Table 10–6.
Table 10–6 Correctable Urologic Abnormalities That Cause Bacterial Persistence
Ultrasonography
The renal ultrasound study is an important renal imaging technique because it is noninvasive, easy to perform, and rapid and offers no radiation or contrast agent risk to the patient. It is particularly useful in identifying calculi and hydronephrosis, pyonephrosis, and perirenal abscesses. A single radiograph for calculi should accompany ultrasonography. Ultrasonography is also useful for diagnosing postvoid residual urine. A disadvantage is that the study is dependent on the interpretative and performance skills of the examiner. Furthermore, the study may be technically poor in patients who are obese or who have dressings, drainage tubes, or open wounds overlying the area of interest.
Computed Tomography (CT) and Magnetic Resonance Imaging (MRI)
The radiologic modalities that offer the best anatomic detail are CT and MRI. They are more sensitive than excretory urography or ultrasonography in the diagnosis of acute focal bacterial nephritis, renal and perirenal abscesses, and radiolucent calculi (Kuhn and Berger, 1981; Mauro et al, 1982; Wadsworth et al, 1982; Soulen et al, 1989; Soler et al, 1997). When used to localize renal and perirenal abscesses, CT improves the approach to surgical drainage and permits percutaneous approaches. MRI has not superseded CT in the evaluation of renal inflammation, but it has provided some advantages in delineating extrarenal extension of inflammation.
Voiding Cystourethrography
The voiding cystourethrogram is an important examination in assessing vesicoureteral reflux. It may be used to evaluate patients with neuropathic bladders and the rare female patient who has a urethral diverticulum causing her persistent infections.
Radionuclide Studies
Hippuran I-131 and technetium-99m (99mTc) glucoheptonate scans are used to detect focal parenchymal damage, renal function impairment, and decreased renal perfusion in acute renal infections (McAfee, 1979). Although gallium-67 scanning has been reported to be useful in the diagnosis of pyelonephritis and renal abscess, it is uncommonly required and may be positive in noninfectious entities. Indium-111–labeled WBC studies have limited efficacy in establishing the presence of an inflammatory focus, particularly when the patient’s clinical presentation does not suggest an infectious process.
Principles of Antimicrobial Therapy
Therapy for UTIs must ultimately eliminate bacterial growth in the urinary tract. This can occur within hours if the proper antimicrobial agent is used (Stamey, 1980). Efficacy of the antimicrobial therapy is critically dependent on the antimicrobial levels in the urine and the duration that this level remains above the minimal inhibitory concentration of the infecting organism (Hooton and Stamm, 1991). Hence, resolution of infection is closely associated with the susceptibility of the bacteria to the concentration of the antimicrobial agent achieved in the urine (McCabe and Jackson, 1965; Stamey et al, 1965, 1974). The concentration of useful antimicrobial agents in the serum and urine of healthy adults is shown in Table 10–7, which demonstrates that the urinary levels are often several hundred times greater than the serum levels. Inhibitory concentrations in urine are achieved after oral administration of all commonly used antimicrobial agents, except for the macrolides (erythromycin). The question of serum levels versus urinary levels is a practical one because the policy of testing antimicrobial susceptibility agents at concentrations obtainable only in the serum discourages the physician from using drugs that are effective at the urinary level; for example, oral penicillin G for E. coli and Proteus mirabilis and tetracycline for P. aeruginosa.
The concentration of the antimicrobial agent achieved in blood is not important in treatment of uncomplicated UTIs. However, blood levels are critical in patients with bacteremia and febrile urinary infections consistent with parenchymal involvement of the kidney and prostate.
In patients with renal insufficiency, dosage modifications are necessary for agents that are cleared primarily by the kidneys and cannot be cleared by another mechanism. In renal failure, the kidneys may not be able to concentrate an antimicrobial agent in the urine; hence, difficulty in eradicating bacteria may occur. Urinary tract obstruction may also reduce concentration of antimicrobial agents within the urine.
A decision regarding the antimicrobial selection and the duration of therapy must consider the spectrum of activity of the drug against the known pathogen or the most probable pathogens based on the presumed source of acquisition of infection, whether the infection is judged to be uncomplicated or complicated, potential adverse effects, and cost. An often underemphasized but important characteristic is the drug’s impact on the bowel and vaginal flora and the hospital bacterial environment. Bacterial susceptibility will vary dramatically in patients exposed to antimicrobial agents and in individuals in inpatient and outpatient settings. It is imperative that each clinician keep abreast of changes that affect antimicrobial use and susceptibility patterns.
Bacterial Resistance
In the past several years, the frequency and spectrum of antimicrobial-resistant UTIs have increased in both the hospital and community. The increasing frequency of drug resistance has been attributed to combinations of microbial characteristics, bacterial selection pressure due to antimicrobial use, and societal and technologic changes that enhance the transmission of drug resistance (Cohen, 1992).
Bacterial resistance may occur because of inherited chromosomal-mediated resistance or by acquired chromosomal- or extrachromosomal (plasmid)-mediated resistance due to exposure of an organism to antimicrobial agents.
Inherited chromosomal resistance exists in a bacterial species because of the absence of the proper mechanism on which the antimicrobial agent can act. For example, Proteus and Pseudomonas species are always resistant to nitrofurantoin.
Acquired chromosomal resistance occurs during therapy for UTIs. Before antimicrobial therapy, relatively resistant bacteria called mutators may be present in the urine at very low concentrations. Frequencies in mutations for high-level antimicrobial resistance are 1000-fold higher in mutators than in normal strains, indicating the increased adaptability of these strains (Miller et al, 2004). The remainder of the bacteria, which are susceptible to the administered antimicrobial agent, will be eradicated by therapy, but within 24 to 48 hours a repeat urine culture will show high bacterial counts of the resistant mutant. In essence, the antimicrobial therapy has selected out the resistant mutant. This phenomenon is most likely to occur when the antimicrobial level in the urine is close to or below the minimal inhibitory concentration of the drug. Selection of resistant clones in the course of therapy for a previously sensitive bacteriuric population occurs between 5% and 10% of the time, clearly not an insignificant factor and one that must be considered in resolving bacteriuria. Underdosing and noncompliance, as well as diuresis induced by increased fluid intake, can contribute to this process. Therefore the clinician should select an antimicrobial agent with a urinary concentration that exceeds the minimal inhibitory concentration by the widest margin possible, avoid underdosing, and emphasize patient compliance.
Extrachromosomal-mediated resistance may be acquired and transferable via plasmids, which contain the genetic material for the resistance. This so-called R-factor resistance occurs in the bowel flora and is much more common than selection of preexisting mutants in the urinary tract. All antimicrobial classes are capable of causing plasmid-mediated resistance. However, for the fluoroquinolones resistance is rarely transmitted by plasmids and nitrofurantoin plasmid-mediated resistance has not been reported. Therefore patients previously exposed to β-lactams, aminoglycosides, sulfonamides, TMP, and tetracycline will often have R-factor resistance to both the antimicrobial agent to which the bacteria were exposed and also to other antimicrobial agents. In addition, the plasmids carrying the resistant genetic material are transferable both within species and across genera. Thus, for example, a patient receiving tetracycline may harbor several bowel strains that are resistant to tetracycline, ampicillin, sulfonamides, and TMP. Because the bowel flora is the major reservoir for bacteria that ultimately colonize the urinary tract, infections that occur after antimicrobial therapy and that can cause plasmid-mediated resistance are commonly caused by organisms with multidrug resistance. However, resistant E. coli in the bowel flora that infect the urinary tract almost always show susceptibility to nitrofurantoin or to the quinolones.
Antimicrobial resistance is also influenced by the duration and amount of antimicrobial agent used. For example, documented increased use of fluoroquinolones in the hospital setting has been directly associated with increased resistance of bacteria (particularly Pseudomonas) to the fluoroquinolones. Resistance tends to increase the longer the agent is used. Conversely, reduction in duration of therapy and in the amount of the drug used may lead to reemergence of more susceptible strains.
Most studies reporting antimicrobial resistance have been based on surveys of laboratory isolates, generally without correlation with clinical or epidemiologic factors (e.g., the presence and nature of symptoms, age, sex, and whether the infection was complicated). Gupta and colleagues (1999) determined the prevalence of and trends in antimicrobial resistance among uropathogens isolated from a large, well-defined population of women with acute uncomplicated cystitis. Over a 5-year period, the prevalence of resistance to TMP/SMX, ampicillin, and cephalothin increased significantly, whereas resistance to nitrofurantoin and ciprofloxacin remained uncommon. However, fluoroquinolone resistance of E. coli has increased from less than 1% to 10% in hospitalized patients (Karlowsky et al, 2003). In a transplant unit, where fluoroquinolones are commonly administered prophylactically, E. coli resistance can be 80%. Previous use of fluoroquinolones and the presence of underlying urologic diseases were the strongest determinants for UTIs caused by resistant strains (Ena et al, 1995). Fluoroquinolone resistance is an increasing problem in some European countries. A multiple-resistant phenotype involving fluoroquinolone resistance is now present in most countries in Europe, and this phenotype is selected for not only by the use of quinolones but also by the use of ampicillin, sulfamethoxazole, and TMP/SMX (Kahlmeter and Menday, 2003). This is a concern because fluoroquinolones, which are associated with chromosomal-mediated but not plasmid-mediated resistance, are the current drug of choice for patients who have been exposed to agents causing plasmid-mediated resistance.
The clinical significance of these in-vitro trends in resistance has been addressed in studies that correlated in-vitro resistance to TMP/SMX with clinical outcome in uncomplicated cystitis and pyelonephritis (Gupta and Stamm, 2002). Clinical failures occurred in 40% to 50% of women if the bacteria were resistant and the bacteriologic failure approached 60%. (For further information on the role of TMP-SMX in prophylaxis, see Bladder Infections, later in this chapter.)
Antimicrobial Formulary
The mechanism of action, reliable coverage, and common adverse reactions, precautions, and contraindications for antimicrobial agents used in the treatment of UTIs are indicated in Tables 10-8, 10-9, and 10-10, respectively.
Table 10–8 Mechanism of Action of Common Antimicrobials Used in the Treatment of UTIs
| DRUG OR DRUG CLASS | MECHANISM OF ACTION | MECHANISMS OF DRUG RESISTANCE |
|---|---|---|
| β-Lactams (penicillins, cephalosporins, aztreonam) | Inhibition of bacterial cell wall synthesis | Production of β-lactamase Alteration in binding site of penicillin-binding protein Changes in cell wall porin size (decreased penetration) |
| Aminoglycosides | Inhibition of ribosomal protein synthesis | Downregulation of drug uptake into bacteria Bacterial production of aminoglycoside-modifying enzymes |
| Quinolones | Inhibition of bacterial DNA gyrase | Mutation in DNA gyrase-binding site Changes in cell wall porin size (decreased penetration) Active efflux |
| Nitrofurantoin | Inhibition of several bacterial enzyme systems | Not fully elucidated—develops slowly With prolonged exposure |
| Trimethoprim-sulfamethoxazole | Antagonism of bacterial folate metabolism | Draws folate from environment (enterococci) |
| Vancomycin | Inhibition of bacterial cell wall synthesis (at β-lactams) | Enzymatic alteration of peptidoglycan different point than target |
Table 10–9 Reliable Coverage of Antimicrobials Used in the Treatment of UTIs of Commonly Encountered Pathogens*
| ANTIMICROBIAL AGENT OR CLASS | GRAM-POSITIVE PATHOGENS | GRAM-NEGATIVE PATHOGENS |
|---|---|---|
| Amoxicillin or ampicillin | Streptococcus Enterococci |
Escherichia coli Proteus mirabilis |
| Amoxicillin with clavulanate | Streptococcus Enterococci |
E. coli P. mirabilis Klebsiella species |
| Ampicillin with sulbactam | Staphylococcus (not MRSA) Enterococci |
P. mirabilis Haemophilus influenzae, Klebsiella species |
| Antistaphylococcal penicillins | Streptococcus | None |
| Staphylococcus (not MRSA) | ||
| Antipseudomonal penicillins | Streptococcus Enterococci |
Most, including Pseudomonas aeruginosa |
| First-generation cephalosporins | Streptococcus Staphylococcus (not MRSA) |
E. coli P. mirabilis Klebsiella species |
| Second-generation cephalosporins (cefamandole, cefuroxime, cefaclor) | Streptococcus Staphylococcus (not MRSA) |
E. coli, P. mirabilis H. influenzae, Klebsiella species |
| Second-generation cephalosporins (cefoxitin, cefotetan) | Streptococcus | E. coli, Proteus species (including indole-positive) H. influenzae, Klebsiella species |
| Third-generation cephalosporins (ceftriaxone) | Streptococcus Staphylococcus (not MRSA) |
Most, excluding P. aeruginosa |
| Third-generation cephalosporins (ceftazidime) | Streptococcus | Most, including P. aeruginosa |
| Aztreonam | None | Most, including P. aeruginosa |
| Aminoglycosides | Staphylococcus (urine) | Most, including P. aeruginosa |
| Fluoroquinolones | Streptococcus* | Most, including P. aeruginosa |
| Nitrofurantoin | Staphylococcus (not MRSA) Enterococci |
Many Enterobacteriaceae (not Providencia, Serratia, Acinetobacter) Klebsiella species |
| Trimethoprim-sulfamethoxazole | Streptococcus Staphylococcus |
Most Enterobacteriaceae (not P. aeruginosa) |
| Vancomycin | All, including MRSA | None |
MRSA, methicillin-resistant Staphylococcus aureus.
* Depends on the antimicrobial agent.
Table 10–10 Common Adverse Reactions, Precautions, and Contraindications for Antimicrobial Agents Used in Treatment of UTI
| DRUG OR DRUG CLASS | COMMON ADVERSE REACTIONS | PRECAUTIONS AND CONTRAINDICATIONS |
|---|---|---|
| Amoxicillin or ampicillin | Hypersensitivity (immediate or delayed) Diarrhea (esp. with ampicillin), GI upset AAPMC Maculopapular rash (not hypersensitivity) Decreased platelet aggregation |
Increased risk of rash with concomitant viral disease, allopurinol therapy |
| Amoxicillin with clavulanic acid | Increased diarrhea, GI upset with amoxicillin/clavulanic acid | |
| Ampicillin with sulbactam | Same as amoxicillin with ampicillin | |
| Antistaphylococcal penicillins | Same as with amoxicillin/ampicillin GI upset (with oral agents) Acute interstitial nephritis (esp. with methicillin) |
|
| Antipseudomonal penicillins | Same as with amoxicillin/ampicillin Hypernatremia (these drugs are given as sodium salt; esp. carbenicillin, ticarcillin) Local injection site reactions |
Use with caution in patients very sensitive to sodium loading. |
| Cephalosporins | Hypersensitivity (less than with penicillins) GI upset (with oral agents) Local injection site reactions AAPMC Positive Coombs test Decreased platelet aggregation (esp. with cefotetan, cefamandole, cefoperazone) |
Should not be used in patients with immediate hypersensitivity to penicillins; may use with caution in patients with delayed hypersensitivity reactions. |
| Aztreonam | Hypersensitivity (less than with penicillins) | Less than 1% incidence of cross reactivity in penicillin-or-cephalosporin-allergic patients; may be used with caution in these patients |
| Aminoglycosides | Ototoxicity: vestibular and auditory components Nephrotoxicity: nonoliguric azotemia Neuromuscular blockade with high levels |
Avoid in pregnant patients. Avoid if possible in patients with severely impaired renal function, diabetes, or hepatic failure. Use with caution in myasthenia gravis patients (owing to potential for neuromuscular blockade). Use with caution with other potentially ototoxic and nephrotoxic drugs. |
| Fluoroquinolones | Mild GI effects; dizziness, lightheadedness; photosensitivity CNS effects, including dizziness, tremors, confusion, mood disorder, hallucinations Tendon rupture |
Avoid in children or pregnant patients due to arthropathic effects. Concomitant antacid or iron or zinc or sucralfate use dramatically decreases oral absorption; use another antimicrobial agent or discontinue sucralfate use while on quinolones. Space administration of quinolones from antacids or iron or zinc products by at least 2 hr to ensure adequate absorption. Ensure adequate patient hydration. These agents can significantly increase theophylline plasma levels (ciprofloxacin and enoxacin seem to have a greater effect than norfloxacin or ofloxacin); avoid quinolones or monitor theophylline levels closely. These agents can lower seizure threshold; avoid in patients with epilepsy and in patients with other risk factors (medications or illness) that may lower the seizure threshold. Monitor glucose levels in patients on antidiabetic agents because hypoglycemia and hyperglycemia have been reported in patients treated concurrently with fluoroquinolones and antidiabetic agents. These agents can enhance warfarin effects; closely monitor coagulation tests. |
| Nitrofurantoin | GI upset Peripheral polyneuropathy (esp. in patients with impaired renal function, anemia, diabetes, electrolyte imbalance, vitamin B deficiency, and debilitated) Hemolysis in patients with G6PD deficiency Pulmonary hypersensitivity reactions can range from acute to chronic and include cough, dyspnea, fever, and interstitial changes |
Do not use in patients with low creatinine clearance (<50 mL/min) because adequate urine concentrations will not be achieved. Monitor long-term patients closely. Avoid concomitant probenecid use, which blocks renal excretion of nitrofurantoin. Avoid concomitant magnesium or quinolones, which are antagonistic to nitrofurantoin. |
| Trimethoprim- sulfamethoxazole | Hypersensitivity, rash GI upset Photosensitivity Hematologic toxicity (AIDS patients) |
Higher incidence of all adverse reactions occurs in AIDS patients and the elderly. Avoid in pregnant patients. Avoid in patients receiving warfarin; concomitant use can significantly elevate prothrombin time. |
| Vancomycin | “Red-man’s syndrome”: flushing, fever, chills, rash, hypotension (histaminic effect) Nephrotoxicity and/or ototoxicity when combined with other nephrotoxic and/or ototoxic drugs Local injection site reactions |
Use with caution with other potentially ototoxic and nephrotoxic drugs. |
AAPMC, antimicrobial-associated pseudomembranous colitis; CNS, central nervous system; GI, gastrointestinal; G6PD, glucose-6-phosphate dehydrogenase.
From McEvoy GK, editor. American Hospital Formulary Service Drug Information. Bethesda (MD): American Society of Health-System Pharmacists; 1995.
Trimethoprim/Sulfamethoxazole
The combination of TMP-SMX has been the most widely used antimicrobial agent for the treatment of acute UTIs. TMP alone is as effective as the combination for most uncomplicated infections and may be associated with fewer side effects (Johnson and Stamm, 1989); however, the addition of SMX contributes to efficacy in the treatment of upper tract infection via a synergistic bactericidal effect and may diminish the emergence of resistance (Burman, 1986) and does attain therapeutic levels in most tissues. TMP alone or in combination with SMX is effective against most common uropathogens, with the notable exception of Enterococcus and Pseudomonas species. TMP and TMP-SMX are inexpensive and have minimal adverse effects on the bowel flora. Disadvantages are relatively common adverse effects, consisting primarily of rashes and gastrointestinal complaints (Cockerill and Edson, 1991). TMP-SMX should be avoided during pregnancy.
Nitrofurantoin
Nitrofurantoin is effective against common uropathogens, but it is not effective against Pseudomonas and Proteus species (Iravani, 1991). It is rapidly excreted from the urine but does not attain therapeutic levels in most body tissues, including the gastrointestinal tract. Therefore it is not useful for upper tract and complicated infections (Wilhelm and Edson, 1987). It has minimal effects on the resident bowel and vaginal flora and has been used effectively in prophylactic regimens for more than 40 years. Acquired bacterial resistance to this drug is exceedingly low. Nitrofurantoin should be used only during the first two trimesters of pregnancy.
Cephalosporins
All three generations of cephalosporins have been used for the treatment of acute UTIs (Wilhelm and Edson, 1987). In general, as a group, activity is high against Enterobacteriaceae and poor against enterococci. First-generation cephalosporins have greater activity against gram-positive organisms as well as common uropathogens such as E. coli and Klebsiella pneumoniae, whereas second-generation cephalosporins have activity against anaerobes. Third-generation cephalosporins are more reliably active against community-acquired and nosocomial gram-negative organisms than other β-lactam antimicrobials. Selective pressure engendered by these broad-spectrum agents should limit their use to complicated infections and situations in which parenteral therapy is required and resistance to standard antimicrobial agents is likely. They are also safe for use during pregnancy.
Aminopenicillins
Ampicillin and amoxicillin have been used often in the past for the treatment of UTIs, but the emergence of resistance in 40% to 60% of common urinary isolates has lessened the usefulness of these drugs (Hooton and Stamm, 1991). The effects of these agents on the normal bowel and vaginal flora can predispose patients to reinfection with resistant strains and often lead to candidal vaginitis (Iravani, 1991). The addition of the β-lactamase inhibitor clavulanate to amoxicillin greatly improves activity against β-lactamase–producing bacteria resistant to amoxicillin alone. However, its high cost and frequent gastrointestinal side effects limit its usefulness. The extended-spectrum penicillin derivatives (e.g., piperacillin, mezlocillin, azlocillin) retain ampicillin’s activity against enterococci and offer activity against many ampicillin-resistant gram-negative bacilli. This makes them attractive agents for use in patients with nosocomially acquired UTIs and as the initial parenteral treatment of acute uncomplicated pyelonephritis acquired outside of the hospital, although less expensive agents are equally effective.
Aminoglycosides
When combined with TMP-SMX or ampicillin, aminoglycosides are the first drugs of choice for febrile UTIs. Their nephrotoxicity and ototoxicity are well recognized; hence, careful monitoring of patients for renal and auditory impairment associated with infection is indicated. Once-daily aminoglycoside regimens have been instituted to maximize bacterial killing by optimizing the peak concentration-to-minimal inhibitory concentration ratio and reduce potential for toxicity (Fig. 10–11) (Nicolau et al, 1995). Administering an aminoglycoside as a single daily dose can take advantage not only of its concentration-dependent killing ability but also of two other important characteristics: time-dependent toxicity and a more prolonged post-antimicrobial effect (Gilbert, 1991; Zhanel et al, 1991). The regimen consists of a fixed 7-mg/kg dose of gentamicin or 5 to 7 mg/kg of tobramycin. Subsequent interval adjustments are made by using a single concentration in serum and a nomogram designed for monitoring of once-daily therapy (Fig. 10–12). Antimicrobial doses are given at the interval determined by the drug concentration of a sample obtained after the start of the initial infusion. For example, if the serum concentration was 7 mg/mL 10 hours after the start of the infusion, subsequent 7 mg/kg doses would be given every 36 hours. This regimen is clinically effective, reduces the incidence of nephrotoxicity, and provides a cost-effective method for administering aminoglycosides by reducing ancillary service times and serum aminoglycoside determinations.

Figure 10–11 Simulated concentration-versus-time profile of once-daily (7 mg/kg/24 hr) and conventional (1.5 mg/kg/8 hr) regimens for patients with normal renal function.
(From Nicolau DP, Freeman CD, Belliveau PP, et al. Experience with a once-daily aminoglycoside program administered to 2,184 adult patients. Antimicrob Agents Chemother 1995;39:650–5.)
Aztreonam
Aztreonam has a similar spectrum of activity as the aminoglycosides, and as with all β-lactams, it is not nephrotoxic. However, its spectrum of activity is less broad than the third-generation cephalosporins. It should be used primarily in patients who have penicillin allergies.
Fluoroquinolones
Fluoroquinolones share a common predecessor in nalidixic acid and inhibit DNA gyrase, a bacterial enzyme integral to replication. The fluoroquinolones have a broad spectrum of activity that makes them ideal for the empirical treatment of UTIs. They are highly effective against Enterobacteriaceae as well as P. aeruginosa. Activity is also high against S. aureus and S. saprophyticus, but, in general, antistreptococcal coverage is marginal. Most anaerobic bacteria are resistant to these drugs; therefore the normal vaginal and bowel flora are not altered (Wright et al, 1993). Bacterial resistance initially appeared to be uncommon, but it is being reported at an increasing rate because of indiscriminate use of these agents (Wright et al, 1993; Vromen et al, 1999).
These drugs are not nephrotoxic, but renal insufficiency prolongs the serum half-life, requiring adjusted dosing in patients with creatinine clearances of less than 30 mL/min. Adverse reactions are uncommon; gastrointestinal disturbances are more common. Hypersensitivity, skin reactions, mild central and peripheral nervous system reactions, and even acute renal failure have been reported (Hootkins et al, 1989). Achilles tendon disorders, including rupture, have been estimated to occur in 20 cases per 100,000 and therefore fluoroquinolone use should be discontinued at the first sign of tendon pain (Greene, 2002). The mechanism of tendon rupture is unclear, but ciprofloxacin stimulates matrix-degrading protease activity from fibroblasts and exerts an inhibitory effect on fibroblast metabolism and synthesis of matrix ground substance, factors that may contribute to tendinopathy (Williams et al, 2000). Administration of the fluoroquinolones to immature animals has caused damage to the developing cartilage; therefore they are currently contraindicated in children, adolescents, and pregnant or nursing women (Christ et al, 1988). There are important drug interactions associated with the fluoroquinolones. Antacids containing magnesium or aluminum interfere with absorption of fluoroquinolones (Davies and Maesen, 1989). Certain fluoroquinolones (enoxacin and ciprofloxacin) elevate plasma levels of theophylline and prolong its half-life (Wright et al, 1993). For most uncomplicated UTIs, the fluoroquinolones have been only slightly more effective than TMP-SMX. However, as resistance to TMP-SMX increases, the fluoroquinolones have distinct advantages in empirical treatment of patients recently exposed to antimicrobial agents and in the outpatient treatment of complicated UTIs (Dalkin and Schaeffer, 1988; Gupta et al, 1999). They may be considered as first-line agents in areas where a significant level of resistance (greater than 20%) exists (in common bacteria) to agents such as ampicillin and TMP-SMX.
Choice of Antimicrobial Agents
Many antimicrobial agents have been shown to be effective in the treatment of UTIs. Factors important in aiding selection of empirical therapy include whether the infection is complicated or uncomplicated; the spectrum of activity of the drug against the probable pathogen; a history of hypersensitivity; potential side effects, including renal and hepatic toxicity; and cost. In addition, favorable or unfavorable effects of the antimicrobial agent on the vaginal and bowel flora are important in women with recurrent UTIs. The bacterial susceptibility and cost of the drug vary dramatically among inpatient and outpatient settings throughout the country. It is imperative, therefore, that each clinician keep abreast of changes in bacterial susceptibility and cost and use current information when choosing antimicrobial agents.
Duration of Therapy
The duration of therapy needed to cure a UTI appears to be related to a number of variables, including the extent and duration of tissue invasion, the bacterial concentration in urine, the achievable urine concentration of the antimicrobial agent, and risk factors (see later) that impair the host and natural defense mechanisms.
Antimicrobial Prophylaxis for Common Urologic Procedures
Principles
Surgical antimicrobial prophylaxis entails treatment with an antimicrobial agent before and for a limited time after a procedure to prevent local or systemic postprocedural infections. For most procedures, prophylaxis should be initiated between 30 minutes and 120 minutes before the procedure (Bratzler and Houck, 2004). Efficacious levels should be maintained for the duration of the procedure and, in special circumstances, a limited time (24 hours, at most) after the procedure (Bratzler and Houck, 2004). Although prospective studies addressing prophylaxis for urologic procedures exist, most focus on only a narrow spectrum of procedures. However, application of the principles of these studies with additional consideration of both the patient and the type of procedure provides a framework for determining when and what type of antimicrobial prophylaxis may be indicated. An additional, nontraditional type of prophylaxis in urology entails periprocedural treatment of the urinary tract with an antimicrobial agent to prevent local or systemic sequelae from the manipulation of colonized hardware such as a stent or urethral catheter.
A wide array of patients undergo invasive procedures in urology. The ability of a host to respond to bacteriuria or bacteremia and the sequelae of a possible infection are two important considerations when assessing the need for antimicrobial prophylaxis. Factors that affect the host’s ability to respond to infection include advanced age, anatomic anomalies, poor nutritional status, smoking, chronic corticosteroid use, other concurrent medication use, and immunodeficiencies such as untreated HIV infection (Table 10–11). Additionally, chronic indwelling hardware, infected endogenous material such as stones, distant infectious sites, and prolonged hospitalizations also increase the risk of infectious complications by increasing the local bacterial concentration and/or altering the spectrum of bacterial flora. The potential seeding of artificial heart valves or prosthetic joints increases the sequelae of a systemic infection in hosts who otherwise may not be at an increased risk of infection. Thus a thorough history and examination of the patient is crucial in directing antimicrobial prophylaxis before a urologic procedure.
Table 10–11 Host Factors That Increase the Risk of Infection
Data from Cruse PJ. Surgical wound infection. In: Wonsiewicz MJ, editor. Infectious disease. Philadelphia: WB Saunders; 1992. p. 758–64; and Mangram AJ et al. Guideline for prevention of surgical site infection, 1999. Hospital Infection Control Practices Advisory Committee. Infect Control Hosp Epidemiol 1999;20:250–78; quiz 279–80.
The type of procedure will also help direct the timing, duration, and spectrum of antimicrobial prophylaxis needed (see Table 10–12 for a summary of antimicrobial prophylaxis recommendations). Consideration should be given to the extent of the local tissue injury incurred and the anticipated type of flora at the site.
Antimicrobial prophylaxis is not without morbidity because allergic complications, although rare, may result in minor reactions such as rash or gastric disturbances or significant sequelae such as early withdrawal of therapy, allergic nephritis, or anaphylaxis.
Urethral Catheterization and Removal
The indications for the routine use of prophylactic antimicrobial agents before urethral catheterization vary and depend on the health, sex, and specific living circumstances of the individual patient as well as on the indication for catheterization (Schaeffer, 2006). The risk of infection after one-time urethral catheterization is 1% to 2% in healthy domiciliary women; however, this risk rises significantly in hospitalized patients (Turck et al, 1962; Thiel and Spuhler, 1965). Thus for patients with risk factors for infection (see Table 10–11), antimicrobial prophylaxis with an oral agent such as TMP-SMX or a fluoroquinolone should decrease the risk of postprocedural infection (see Table 10–12).
Prolonged use of an indwelling urethral catheter is common in hospitalized patients and is associated with an increased risk of bacterial colonization, with a 3% to 10% incidence of bacteriuria per catheter day in one study and 100% incidence of bacteriuria with long-term catheterization (>30 days) (Kass, 1956; Nickel et al, 1985; Liedl, 2001). Prophylactic administration of antimicrobial agents during catheterization is not generally recommended because bacterial resistance can develop rapidly and complicate subsequent antimicrobial treatment (Clarke et al, 2005). This is supported by the Cochrane Database of Systematic Reviews that concluded that antimicrobials given postprocedurally until removal or for the first three postoperative days did not reduce rates of bacteriuria or infection (Niël-weise and Van der Broek, 2005).
The natural history of bacteriuria after catheter removal has not been comprehensively studied. Harding and associates (1991) reported that in asymptomatic bacteriuric women who had been catheterized for 4 to 6 days, 25% developed a UTI within 14 days of catheter removal. In this study, 1-day treatment with TMP-SMX was as effective as a 10-day course at resolving infections. Similar studies on the natural history of postcatheterization bacteriuria have not been performed in male patients. Note that antimicrobial treatment before removal of an indwelling catheter in a patient suspected of having bacteriuria is not considered prophylaxis but rather is treatment for a presumptive UTI and duration of treatment generally should follow previously outlined guidelines for uncomplicated or complicated UTIs.
Data from Polastri and colleagues (1990) suggest that antimicrobial prophylaxis for chronic indwelling catheter changes is not indicated. In their study of 46 catheter changes, bacteremia occurred 4% of the time and when noted was associated with very low concentrations of bacteria in the cultures. Systemic sequelae were not noted.
Urodynamics
Urodynamics, like cystoscopy, is a minimally traumatic procedure with limited urothelial injury that poses a small risk of local infection in hosts with normal anatomy and immune response. Several recent studies support this notion. In a series of women with urinary incontinence randomized to receive 1 day of nitrofurantoin or placebo, Cundiff and coworkers (1999) noted no difference in postprocedural UTI (5% vs. 7%) 1 week after evaluation. Similarly, Peschers and associates (2001) reported infections 1 week after multichannel urodynamics in 5% and 6% in nondiabetic women treated with placebo or cotrimoxazole. Conversely, Kartal and colleagues (2006) demonstrated a reduction in UTIs from 14% to 1% with administration of a single dose of ciprofloxacin in a blinded 192 patient trial. Most series examining the use of antimicrobial prophylaxis exclude patients with altered anatomy such as large prostates or comorbidities, including neurogenic bladder, spinal cord injury, or diabetes, all factors that increase the risk of infection. This is illustrated in work performed by Payne and colleagues in which frequencies of bacteriuria after urodynamics were much higher in men (36%) compared with the women studied (15%) (Payne et al, 1988). In sum, antimicrobial prophylaxis should be considered for patients with a more complex clinical history or anatomy such as men with large postvoid residual amounts or spinal cord–injured patients.
Transrectal Ultrasound-Guided Prostate Biopsy
The use of prophylactic antimicrobials for transrectal ultrasound-guided prostate biopsy reduces postprocedural fever and UTI in most studies. The class and duration of antimicrobial treatment are more varied and controversial. One major population-based screening program reported fever (>38.5° C [101.3° F]) in 3.5% of cases utilizing 1 day of TMP-SMX for most cases and ciprofloxacin for patients with comorbid conditions. This series did not report the frequency of UTIs. Alternatively, Sieber and associates (1997) reported a 0.1% rate of UTI in a large community-based practice in men given 4 days of ciprofloxacin. More recent studies suggest a single-dose/day of fluoroquinolones is as effective as 3 days of treatment (Sabbagh et al, 2004). Together these data suggest that a minimum of 1 day of an antimicrobial agent is indicated for transrectal ultrasound-guided prostate biopsies and that in otherwise healthy men confounding factors including cost of drugs can help direct the class and duration of therapy (Griffith et al, 2002).
Shockwave Lithotripsy
The incidence of UTIs after shockwave lithotripsy is reported to range from 0% to 28% without antimicrobial prophylaxis. A recent meta-analysis of contemporary randomized controlled trials examined the utility and cost-effectiveness of antimicrobial prophylaxis for shockwave lithotripsy and demonstrated, in individuals with sterile preprocedure urine cultures, a reduction in the rate of UTIs after shockwave lithotripsy from 5.7% to 2.1% (Pearle and Roehrborn, 1997). This analysis also demonstrated cost-effectiveness of prophylaxis when consideration was given for the treatment of the rare but more morbid complications of urosepsis and pyelonephritis. A history of a recent UTI or of infectious stones should warrant a full treatment course of antimicrobial agents before shockwave lithotripsy.
Endoscopic Procedures: Lower Urinary Tract
Cystoscopy
Cystoscopy is a minimally traumatic procedure with limited urothelial injury performed on a diverse spectrum of patients including young healthy women and older men. Several prospective trials (Manson, 1988; Clark and Higgs, 1990; Burke et al, 2002) of patients with preprocedure sterile urine report culture-proven rates of UTI between 2.2% and 7.8% after cystoscopy without antimicrobial prophylaxis. In Clark’s report the risk of infection was higher in patients with a previous history of UTI. In a similarly designed study, Rane and colleagues (2001) report a significantly higher postprocedure culture-proven infection rate of 21% without antimicrobial prophylaxis. More recently, Johnson and colleagues (2007) reported a randomized controlled trial of over 2000 patients that demonstrated reductions in bacteriuria with administration of single-dose trimethoprim or ciprofloxacin. In all the studies, single doses of antimicrobial agents reduced infections to between 1% and 5%. In none of these studies were significant systemic infections reported after the cystoscopic procedures.
Together these studies illustrate two key concepts: (1) despite appropriate periprocedural preparation, a small inoculum of bacteria is likely introduced into the bladder during cystoscopy and (2) the significance of the bacteriuria is dependent on host factors, including the ability to mount an appropriate immune response to bacterial inoculation and the ability to clear the bacterial inoculation. For example, in a man with urinary retention, a small inoculum of bacteria could persist and divide in the retained fraction of urine and result in a symptomatic infection. In a host with a reduced ability to respond to infection this bacteriuria could become significant. In contrast, a middle-aged woman undergoing cystoscopy for microscopic hematuria is more likely to efficiently empty her bladder and clear the inoculum but may be exposed to an increased inoculum of bacteria if inappropriately prepared for the examination. Thus we recommend prophylaxis when aberrant host factors could increase the probability or significance of an infection (see Table 10–12). A single dose of a fluoroquinolone is commonly used but other agents such as trimethoprim have also been utilized.
Transurethral Resection of the Prostate and Bladder
Therapeutic transurethral lower urinary tract procedures increase the risk of localized infections compared with simple diagnostic cystoscopy. Although not delineated in any prospective studies, several risk factors likely increase infectious complications, including trauma to the mucosa, increased duration and/or degree of difficulty of the procedure, pressurized irrigants, and manipulation or resection of infected material. The most well-studied lower urinary tract procedure is transurethral resection of the prostate. In a meta-analysis of 32 studies (Berry and Barratt, 2002), a risk reduction was noted in bacteriuria from 26% to 9% on postoperative urine cultures obtained 2 to 5 days after the procedure for patients treated with prophylactic antimicrobial agents. Similarly, septicemia (defined as rigors, persistently elevated temperature [>38.5° C], and an elevated C-reactive protein level) decreased from 4.4% to 0.9% with antimicrobial prophylaxis. The most effective antimicrobial classes included fluoroquinolones, aminoglycosides, cephalosporins, and TMP/SMX (Bactrim, cotrimoxazole). Single doses of antimicrobial agents did lower the relative risk of bacteriuria but not as significantly as antimicrobial agents administered for short courses (2 to 5 days) while the urethral catheter remained in place. Although continuation of antimicrobial therapy while the catheter is in place is not truly prophylaxis, continuation of the initial prophylactic antimicrobial agent for an anticipated short period of time (with catheter in place) does not increase the risk of developing antimicrobial-resistant organisms. No recent trials have investigated prophylaxis for transurethral resection of bladder tumors; however, evidence from transurethral resection of the prostate procedures would suggest that prophylaxis would reduce bacteriuria in these procedures.
Patients who are known preoperatively to have UTIs should have the infections eradicated before the procedure is started; hence, in these patients, preoperative antimicrobial agents are therapeutic and not prophylactic. Failure to eradicate bacteriuria results in bacteremia in 50% of patients (Morris et al, 1976).
Diagnostic and therapeutic upper tract studies are performed with pressurized irrigants and may induce urothelial injury. Prophylaxis with antimicrobial agents that cover uropathogens is indicated.
Endoscopic Procedures: Upper Urinary Tract
Ureteroscopy
Diagnostic and therapeutic upper tract endoscopic procedures have an increased risk of localized infections compared with simple diagnostic cystoscopy due to several factors, including increased trauma to the mucosa, increased duration and/or degree of difficulty of most ureteroscopic procedures, increased pressure of irrigants, and (when applicable) manipulation or resection of infected material. The use of antimicrobial prophylaxis is supported by a randomized trial by Knopf and colleagues (2003) in which prophylactic fluoroquinolone administration significantly reduced postprocedure UTIs in a healthy population of individuals with ureteral stones and uninfected preoperative urine. If an infection or infectious material is suspected, culture and a full treatment course of an appropriate antimicrobial is recommended before the procedure.
Percutaneous Procedures
Percutaneous renal surgery is commonly performed for large renal stones, ureteropelvic junction obstruction, and transitional cell carcinoma surveillance. Pyrexia and bacteremia occur frequently and likely stem from a combination of renal parenchymal injury, pressurized irrigation, and, in some cases, manipulation of infectious stones. Several studies demonstrated a relationship between the risk of postoperative infectious complications (including bacteriuria and sepsis) and the duration of the procedure and amount of irrigant used (Dogan et al, 2002). If preoperative urine cultures are positive, treatment of the infection should occur before surgery. Conversely, if preoperative cultures are negative, antimicrobial prophylaxis covering common urinary pathogens should be instituted (Wolf et al, 2008) (see Table 10–12).
Open and Laparoscopic Surgery
Open surgical procedures can be classified as clean, clean contaminated, contaminated, and dirty (Table 10–13). Antimicrobial prophylaxis is indicated for clean contaminated and contaminated wounds, whereas antimicrobial treatment with an appropriate agent should be instituted for dirty-infected wounds. To date, no large studies have evaluated the risk of surgical site infections for different laparoscopic urologic procedures. However, data in the general surgery literature suggest that the laparoscopic approach lowers the risk of surgical site infections (Kluytmans, 1997). Clean surgeries in urology include radical nephrectomy if the urinary tract is not entered. All urologic procedures in which the urinary tract is opened electively are considered clean contaminated procedures, whereas entry into an infected urinary tract is considered a contaminated procedure and carries a higher rate of surgical site infection (Cruse, 1992). Antimicrobial agents should be active against the most likely infecting organism and should be administered within 1 hour of the procedure and discontinued 24 hours after because several studies have failed to demonstrate beneficial effects of long courses of prophylaxis (Conte et al, 1972; Goldmann et al, 1977). In the United States, first-generation cephalosporins are commonly used for prophylaxis of clean contaminated procedures because they have low incidences of allergic reactions, long half-lives, and low cost. For patients with a β-lactam allergy, the 2004 National Surgical Infection Prevention Project (NSIPP) guidelines recommend either vancomycin or clindamycin. Prophylaxis for urinary reconstruction with intestine requires increased anaerobic coverage, and thus use of second-generation cephalosporins is recommended (Bratzler and Houck, 2004). When use of the colon or appendix is anticipated for urologic reconstruction, the 2004 NSIPP recommendations include orally administered antimicrobial bowel preparation (neomycin plus erythromycin or neomycin plus metronidazole) 18 to 24 hours before surgery and parenteral cefotetan or cefoxitin 30 to 60 minutes before incision (Bratzler and Houck, 2004). Recommendations for patients with a β-lactam allergy include clindamycin plus gentamicin, aztreonam, or ciprofloxacin. Dirty wounds in urology include all abscesses and traumatic perforation of the genitourinary tract. Treatment of a dirty wound should begin with broad coverage of anticipated organisms and intraoperative wound cultures. Subsequent therapy and treatment duration depends on the sensitivities of the cultured organism.
Table 10–13 Surgical Wound Classification
| Clean | Uninfected wound without inflammation or entry into the genital, urinary, or alimentary tract Primary wound closure ± closed drainage |
| Clean contaminated | Uninfected wound with controlled entry into the genital, urinary, or alimentary tract Primary wound closure ± closed drainage |
| Contaminated | Uninfected wound with major break in sterile technique (gross spillage from gastrointestinal tract or nonpurulent inflammation) Open fresh accidental wounds |
| Dirty infected | Wound with preexisting clinical infection or perforated viscera Old traumatic wounds with devitalized tissue |
Adapted from Mangram AJ, Horan TC, Pearson ML, et al. Guideline for prevention of surgical site infection, 1999. Hospital Infection Control Practices Advisory Committee. Infect Control Hosp Epidemiol 1999;20:250–78; quiz 279–80.
Special Considerations
Patients with Risk of Endocarditis
The risk of endocarditis after urologic procedures is low; however, the urinary tract is the second most common site of entry of organisms that cause endocarditis (Dajani et al, 1997). Nonetheless, the 2007 American Heart Association’s updated guidelines no longer recommend antimicrobial prophylaxis solely to prevent infectious endocarditis. This recommendation is based on an overall assessment that antimicrobial prophylaxis during genitourinary procedures is not an effective strategy for the prevention of infectious endocarditis and is outweighed by the risk of antimicrobial-related adverse events.
Patients with Indwelling Orthopedic Hardware
Bacterial seeding of implanted orthopedic hardware is a rare but morbid event. A joint commission of the American Urological Association, the American Academy of Orthopaedic Surgeons, and infectious disease specialists convened in 2003 and released an advisory statement on antimicrobial prophylaxis for urologic patients with total joint replacement (American Urological Association and American Academy of Orthopaedic Surgeons, 2003) (Table 10–14). In general, antimicrobial prophylaxis for urologic patients with total joint replacements, pins, plates, or screws is not indicated. Prophylaxis is advised for individuals at higher risk of seeding a prosthetic joint, including those with recently inserted implants (within 2 years) and/or host risk factors as delineated earlier. Prophylaxis on the basis of potential seeding of a prosthetic joint should be instituted for procedures including stone manipulation, transmural incision of the urinary tract, upper tract endoscopic procedures, procedures involving bowel segments, and transrectal prostate biopsy. Additionally, patients with recent prosthetic joints or compromised host factors and urinary diversions, indwelling stents or catheters, a recent history of urinary retention, or UTIs should receive antimicrobial prophylaxis before urinary tract procedures. The AUA Advisory Statement recommends for these patients either an oral quinolone or ampicillin, 2 g IV (vancomycin, 1 g IV over 1 to 2 hours for ampicillin-allergic patients), and gentamicin, 1.5 mg/kg IV, 30 to 60 minutes before the procedure.
Table 10–14 Antimicrobial Regimens for Patients with Indwelling Orthopedic Hardware
| PATIENT TYPE | ANTIMICROBIAL RECOMMENDATION |
|---|---|
| Total joint inserted >2 years ago, pins, plates, screws + no host risk factors | Not recommended empirically |
| Total joint inserted <2 years ago or aberrant host factor(s) | Oral quinolone or ampicillin, 2 g IV + gentamicin, 1.5 mg/kg IV, 30-60 min before procedure Substitute vancomycin, 1 g IV, over 1-2 hr before procedure if ampicillin allergy |
From American Urological Association, American Academy of Orthopaedic Surgeons. Antibiotic prophylaxis for urological patients with total joint replacements. J Urol 2003;169:1796–7.
Key Points
Antimicrobial Prophylaxis for Common Urologic Procedures




